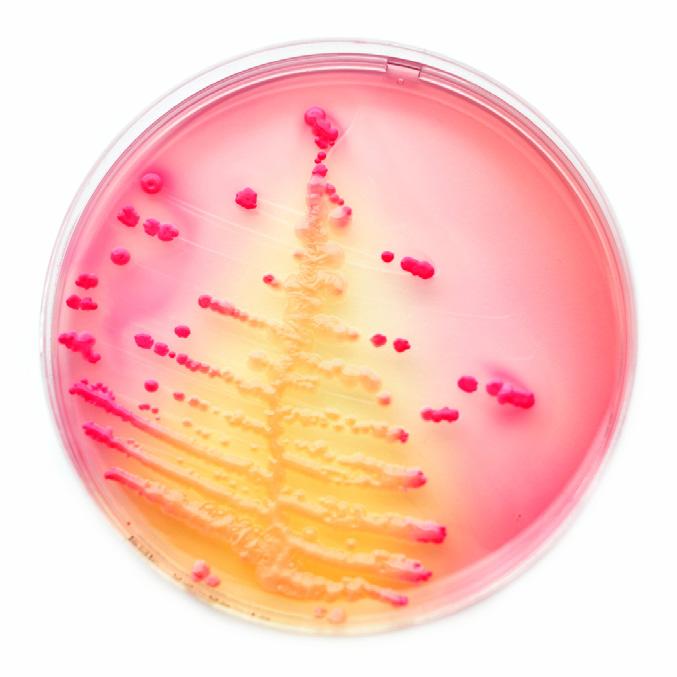

Farmasiliv 03



Fra hjemmesykepleie til apotek
Etter åtte år i hjemmesykepleien på Oppdal hadde
Therese Flotten Volden behov for en endring.

![]()



Fra hjemmesykepleie til apotek
Etter åtte år i hjemmesykepleien på Oppdal hadde
Therese Flotten Volden behov for en endring.

Et steg nærmere felles pasientjournal De nye reglene for pasientjournal gjelder også for apotekansatte.
Medisinstart Farmasiforbundet er skuffet over manglende involvering, og er bekymret for gjennomføringsevnen.


3 Forbundslederen har ordet
6 Småstoff
10 Medisinstart
16 Et steg nærmere felles pasientjournal
20 Tidlig spesialisering for apotekteknikere
22 Fra Radium til Black Lion
24 Årets tariffoppgjør
26 Fra hjemmesykepleie til apotek
Den nye, offentlig finansierte apotektjenesten Medisinstart er endelig en realitet. Men Farmasiforbundet er skuffet over manglende involvering, og er bekymret for gjennomføringsevnen.
28 Ferietid og ferieloven
32 Drømmer om å mekke Norges nye kampfly
36 Parat informerer
38 Spørsmål fra medlemmer
40 Kryssord, sudoku, anagram og på kryss og tvers
42 Leder i Parat
43 Hjelp når du trenger det



Utdanningsdirektoratet og Faglig råd for helse- og oppvekstfag (FRHO) har jobbet for å utvikle kvaliteten i utdanningen av helse- og oppvekstfagene på videregående nivå. Det skal de fortsette med.

Apotektekniker Tigist Lule har jobbet for Farmasøyter uten grenser. Kompetanse i kombinasjon med å beherske det etiopiske språket amharisk førte henne til Black Lion Hospital i Addis Abeba.
Et steg nærmere felles pasientjournal
De nye reglene for pasientjournal gjelder også for apotekansatte. Forskriften er på høring denne sommeren og skal deretter følges opp med en ny forskrift som vil definere nærmere hvordan apotekene skal håndtere helseopplysninger.

Etter åtte år i hjemmesykepleien på Oppdal hadde Therese Flotten Volden behov for en endring i arbeidssituasjonen og sykepleieren fant sin plass på apoteket i fjellbygda.

Jeg har gjort det igjen. «Døgnet». Ikke som i ungdommen, der «døgning» var forbundet med fest, fyll og moro. Nei, jeg har tilbrakt natten hos Riksmekleren i Grensen i Oslo. Ikke i Farmasiforbundets tjeneste denne gangen, men på jobb for YS-Stat og på vegne av over 20 000 statsmedlemmer, rundt 10 000 av dem i Parat.
Det er noe eget ved å oppleve soloppgangen fra meklerens terrasse. Det gjorde jeg sammen med folk fra både YS, LO, Unio, Akademikerne og Kommunal- og moderniseringsdepartementet. På mange måter virker det meningsløst at flere titalls mennesker i forhandlingsdelegasjonene skal sitte i triste møtelokaler en hel natt
og vente mens noen få er inne og forhandler, men det skjer noe med dynamikken når alle har kniven på strupen og må bli enige eller uenige før en frist. Man kommer alltid i mål med enighet –eller uenighet og streik. Det siste skjer heldigvis sjelden.
Fristen blir ofte overskredet med en del timer, noen ganger litt for mange timer, men likevel. Vi er med på noe viktig – nemlig å holde den norske arbeidslivsmodellen i gang, der arbeidstakere, arbeidsgivere og staten samarbeider om at arbeidslivet skal fungere best mulig. Til glede for alle i landet vårt. Det er en sak det er verdt å «døgne» for.

Utgis av: Farmasiforbundet i Parat
Farmasforbundet, Lakkegata 23
Postboks 9029 Grønland 0133 OSLO
www.farmasiforbundet.no www.parat.com
Besøksadresse: Lakkegata 23
Telefon: 21 01 36 00
Teleaks: 21 01 38 00
E-post: post@parat.com
Ansvarlig redaktør: Trygve Bergsland
Mobil: 905 85 639
E-post: trygve.bergsland@parat.com
Leder: Irene Hope Mobil: 958 00 766
E-post: irene.hope@parat.com
Forsidefoto: Vetle Daler. Avbildet: Tigist Lule. Radiumhospitalet: mararie, flickr.
Alle illustrasjonsbilder i bladet som ikke er kreditert er levert av iStock.
Redaksjonen avsluttet: 11.6.2018 Materiellfrist neste nr: 3.9.2018
ISSN: 1891-6864
ISSN: 2464-1618 (online)
Layout: 07 Media, avd. Moss www.07.no
Telefon: 22 79 95 00
Trykk: Ålgård Offset AS www.a-o.no
Telefon: 51 61 15 00 farmasiforbundet


De sentrale tarifforhandlinger er i havn, og nå gjenstår de lokale forhandlinger i kjeder og foretak.
I år har det vært et litt spesielt oppgjør fordi vi skulle hatt forbundsvise oppgjør som vi vanligvis har hvert andre år og forhandlet direkte på tariffavtalen, men slik ble det ikke. Det er frontfaget (Parat, Fellesforbundet og Norsk Industri) som legger premissene for hvordan forhandlingene som kommer etter deres forhandlinger skal foregå. I år bestemte imidlertid hovedorganisasjonene seg for å gå samordnet for å sikre felles krav opp mot arbeidsgiver for å stå sterkere sammen, noe som også gjelder oss. Neste hovedoppgjør blir om to år og gjennomføres i 2020.
For Farmasiforbundets del i privat sektor (Virke-området) mener jeg vi er kommet godt ut av disse forhandlingene. Vi har fått 3,75 kroner sentralt, og i skrivende stund blir det i tillegg lokale forhandlinger på kjedenivå. Jeg håper de lokale forhandlingene blir ferdig før sommeren.
Når det gjelder sykehusapotekene, så er det slik at informasjonen på dette området kommer senere. Dette er et annet forhandlingssystem enn i privat sektor og er mer krevende å gjennomføre. Mer informasjon om tariffoppgjørene vil bli sendt ut så snart resultatet foreligger.
Nye helsetjenester er på god vei inn i apotek, og jeg vil på det sterkeste anbefale alle å følge med på utviklingen og ta del i de nye oppgavene som kommer. I en travel hverdag kan dette være en utfordring spesielt på små apotek med liten bemanning.
Apotekteknikere utgjør ca. 50 prosent av fagpersonalet i apotek, og da mener jeg det er viktig å utvikle kompetansen som kan bidra til å sikre gode helsetjenester i apotek. Jeg håper og tror at apotekkjedene vil legge til rette for at apotekteknikere får den kompetansen som skal til for å sikre god informasjon og veiledning om nye helsetjenester.
Skal vi beholde apotekene som en faghandel i fremtiden, så må hele bransjen ta inn over seg at apotekteknikere også må bli involvert i utviklingen av nye helsetjenester. Nye helsetjenester er en fin anledning til faglig utvikling for hele personalet. Apotekteknikere er en del av helsepersonellet i apotek, og den samlende kompetansen på apotek må bygges opp rundt alt helseper sonell som arbeider der.
Farmasiforbundet jobber for faget, yrket og bransjen og er svært opptatt av kompetanse og fagut danning for apotekteknikere.
Ønsker alle en strålende sommer!


Stig A. Slørdahl overtar som leder for Beslutningsforum for nye metoder, ifølge en pressemelding.
Beslutningsforum bestemmer hvilke medikamenter som skal brukes i Norge. Slørdahl kommer fra jobben som administrerende direktør i Helse Midt-Norge og etterfølger Lars Vorland som har ledet Beslutningsforum i fire år.
Stig A. Slørdahl er ny leder i Beslutningsforum. Foto: Helse Midt-Norge.

Sykepleiermangelen opp 47 prosent på ett år
Mangelen på sykepleiere og spesialsykepleiere har økt med 47 prosent det siste året. Det kan gå utover pasientsikkerheten, sier forbundsleder. Ifølge NAVs bedriftsundersøkelse mangler det i år 5900 personer i slike stillinger, mot 4000 i fjor, skriver NRK.
Forbundsleder Eli Gunhild By i Norsk Sykepleierforbund sier de nå er inne i en varslet krise.
– Når man ikke har nok sykepleiere på jobb, kan det føre til for eksempel feilmedisinering, infeksjoner eller psykiske lidelser hos pasienter som ikke blir ivaretatt.
By sier arbeidsgiver har et stort ansvar, men vektlegger at politikerne må bevilge nok penger. (NTB)



Uetisk å fortsette med akupunktur på spedbarn
Fagansvarlige ved nyfødtscreeningen på Rikshospitalet ønsker å teste alle nyfødte barn for muskelsykdommen spinal muskelatrofi (SMA).
De forbereder en søknad til Helse- og omsorgsdepartementet, skriver NRK. – Nå har det kommet en målrettet behandling. Alle undersøkelser viser at jo tidligere du starter behandling, jo bedre går det, sier Terje Rootwelt, professor og klinikkleder ved Barne- og ungdomsklinikken ved Oslo universitetssykehus.
Beslutningsforum for nye metoder sa i februar ja til at alle barn under 18 år som har sykdommen, skal få medisinen Spinraza. (NTB)
Lege Holgeir Skjeie har selv brukt nåleakupunktur mot spedbarnskolikk. Nå viser forskningen hans at slik behandling ikke har effekt og kan påføre barna smerte. – Vi har for første gang vist at dette ikke har effekt. I tillegg kan det påføre smerte, og mange av barna gråter når de får nålene satt. Da er det uetisk for autorisert helsepersonell å drive med dette. Det faller mange tungt for brystet å høre, men disse barna kan ikke bestemme selv, og da må vi gjøre det som er rett, sier Skjeie. (NTB)
Rundt 20 000 ender skal avlives i Danmark etter funn av fugleinfluensa i en andebesetning. Funnet ble gjort under en rutinemessig inspeksjon nær Holstebro nordvest på Jylland, opplyste det danske mattilsynet, Fødevarestyrelsen, søndag.
Hele besetningen på rundt 20 000 ender blir derfor avlivet, og det opprettes en sikkerhetssone på 1 kilometer rundt besetningen.
Det dreier seg om såkalt lavpatogen fugleinfluensa av typen H5, som er mild sammenlignet med andre typer fugleinfluensa. Vanligvis dør ikke fjærkre av denne typen fugleinfluensa, men sykdommen kan spre seg, utvikle seg og bli mer alvorlig og dødelig. (NTB)
Mange pasienter føler seg utsatt for krenkelser når de blir utsatt for tvang. Mange unge oppfatter tvangsmating som mishandling.
For mange pasienter kan tvungen behandling de ikke kan slippe unna, bryte ned selvbildet. Flere pasienter har negativ erfaring med tvungent psykisk helsevern og bruker uttrykk som konsentrasjonsleir, viser flere studier Olav Nyttingnes har utført blant unge og voksne pasienter som har fått behandling ved norske psykiatriske sykehus, skriver Forkning.no. (NTB)



Ni dollar per person årlig. Det er alt det ville koste å gi kvinner i fattige land full tilgang til moderne prevensjon og gravide helsehjelpen de trenger.
Likevel er det hvert år 200 millioner kvinner i utviklingsland som ikke bruker moderne prevensjon, selv om de ønsker å unngå å bli gravide. 45 millioner kvinner har ingen eller dårlig fødsels- og barselomsorg. Tallene kommer fram i en stor rapport som er publisert i tidsskriftet The Lancet. (NTB)
Hyppige besøk i badstue reduserer risikoen for å få slag kraftig, viser ny forskning.
Forskere ved Östra Finlands universitet har funnet ut at den som sitter i badstue fire til sju ganger i uka, reduserer risikoen for å få slag med hele 61 prosent. Selv to–tre badstubesøk i uka gir positiv helseeffekt og reduserer risikoen for slag med 14 prosent, ifølge forskerne.
Professor Hans Hägglund ved Akademiska sjukhuset i Uppsala er overrasket over at effekten er så høy, men forstår hvorfor badstue er bra for hjerte- og karsystemet.
– Det som skjer når man tar badstubad, er at de perifere blodkarene utvides, og at blodtrykket minker, sier han. (NTB)


Helseindustrien har hatt en rekordvekst de siste tre årene, viser en rapport. Samlet ligger veksten på 4,5 milliarder kroner i året. Siden 2014 har næringen for alvor tatt av, viser rapporten fra Menon Economics, som er blitt presentert.
I 2016 vokste næringen med nesten 9 prosent, og i fjor anslås veksten å ligge på 9,5 prosent. For 2018 ligger prognosen på 8,8 prosents vekst. (NTB)

Australske myndigheter leter etter svar på hvorfor en mystisk kjøttetende bakterie sprer seg sør i landet. Forskere har ikke klart å finne ut hvordan bakterien som danner burulisår, sprer seg.
Infeksjonen forårsaker store skader i hud og vev og kan føre til langvarig handikap, deformering, amputering og til og med død.
– Dette er en forferdelig og smertefull lidelse, og det er helt nødvendig med videre forskning for å komme til bunns i denne nye helseutfordringen, sier Australias helseminister Greg Hunt. Regjeringen bevilger nå ni millioner kroner i håp om å kunne løse mysteriet. (NTB)

Det var en liten økning av utbrudd av smittsomme sykdommer i 2017, melder Folkehelseinstituttet. Underrapportering er fortsatt et problem. I 2017 ble det varslet 162 utbrudd med totalt 2320 rapporterte sykdomstilfeller. Dette er litt mer enn i 2016, men på samme nivå som årene før, heter det i Folkehelseinstituttets ferske rapport.
Ved 36 av utbruddene var det mistanke om smitte fra næringsmidler. Over 60 prosent av alle utbrudd ble varslet fra helseinstitusjoner. (NTB)

I alt 19 leger har måttet tilbakebetale til sammen 13 millioner kroner for feilutbetalinger i 2015 og 2016, men ingen er straffet, og alle beholdt jobben. Samtidig har NAV de tre siste årene anmeldt mellom 1000 og 1500 personer for trygdesvindel – hvert år. I snitt dømmes rundt 900 personer hvert år for grovt bedrageri etter anmeldelser fra NAV. De aller fleste av dem har fått fengselsstraff, melder NRK.
I 2015 og 2016 kontrollerte legenes kontrollorgan Helfo til sammen 19 fastleger for bruk av taksten som er den største refusjonsutbetalingen fra Helfo til fastleger. Samtlige hadde uriktig takstbruk for beløp fra 150 000 opptil 1,3 millioner kroner. (NTB)
Det regjeringsoppnevnte Akuttutvalget pekte på risikoen ved operatørbytte i luftambulansetjenesten allerede i 2015.
«Offentlig drift av den operative luftambulansetjenesten bør utredes», var rådet helseminister Bent Høie (H) fikk av Akuttutvalget i desember 2015, ifølge Klassekampen. Rapporten viste til «en fare for at operatørbytte ved inngåelse av nye kontrakter bryter en god samhandling som er opparbeidet mellom operatør og helseforetak gjennom flere år».

Den tiden har akuttberedskapen i Norge vært svekket fordi ambulansefly har stått på bakken. Krisen i luftambulansetjenesten oppsto i kjølvannet at det britiskeide selskapet Babcock vant kontrakten om å drifte tjenesten over Lufttransport. (NTB)
Helfo vil gå fra å ha 22 kontorsteder til 6, fastslår regjeringen. Det rammer 165 av Helfos ansatte.
Regjeringen har besluttet at 16 kontorer med rundt 165
Helfo-ansatte skal nedlegges. Det vil ramme kontorer i Oslo, Bergen, Kristiansand, Voss, Eidsvoll, Kongsberg, Risør, Harstad, Gloppen, Vågå, Verdal, Nærøy, Lenvik, Beiarn, Orkdal og Brumunddal.
Helfo, som er Helsedirektoratets ytre etat, varslet i 2017 behov for en ny kontorstruktur for å oppnå effektiv ressursutnyttelse. Økt bruk av selvbetjening og automatisering og færre enkle, manuelle arbeidsoppgaver har redusert behovet for ansatte. (NTB)

Nesten sju av ti unge tør ikke utføre førstehjelp i alle livstruende situasjoner. – Det er skremmende at så mange unge verken tør gi førstehjelp eller kjenner til nødnummeret 113. Her har samfunnet en kjempemulighet til å gi livreddende kunnskap til svært mange mennesker som kan være i stand til å redde livet til venner, familie og mannen i gata, sier president i Røde Kors, Robert Mood.

Undersøkelsen viser at bare snaut fire av ti unge tør gi førstehjelp i livstruende situasjoner, og omtrent like mange kan nødnummeret 113, ifølge tallene Respons Analyse har hentet inn på vegne av Røde Kors. (NTB)
FARLIGE TABLETTKOPIER I OMLØP IGJEN
I TRONDHEIM Potensielt livsfarlige tabletter selges på gata i Trondheim. Overdoseteamet i kommunen frykter at rusmiddelet sprer seg.
Tablettene utgir seg for å være Xanax, et angstdempende preparat med virkestoffet alprazolam. Men tester ved St. Olavs hospital viser at preparatet inneholder opiatet fentanyl – et virkestoff som har ført til flere overdosedødsfall, skriver NRK.
Man regner med tablettene er laget i Øst-Europa og har funnet veien til Norge via det mørke nettet. De fikk først kjennskap til tablettene tidligere i år. Nå er de i omløp igjen. Lav pris gjør at de frykter tablettene vil spre seg rundt om i landet. (NTB)

På ett år har bruken av sovemedisin blant barn i alderen 5 til 9 år økt med 20 prosent, viser tall NRK har hentet fra Reseptregisteret.

– Du skal ikke måtte gå på sovemedisiner når du er så liten. Det eneste unntaket er om barnet har spesifikke nevrologiske tilstander, men dette er sjelden, sier seniorforsker og søvnekspert ved Folkehelseinstituttet Børge Sivertsen til NRK.
Tall i registeret viser at i 2016 fikk 2999 barn resept på sovemedisiner, mens det i fjor var 3642 barn som tok piller for å sove.
Sivertsen tror økningen først og fremst kommer av endrede holdninger til sovemedisin. (NTB)
Å miste sin partner på sine eldre dager kan føre til raskere tap av kognitive evner. Men forfallet bremses hvis man har søsken eller voksne barn, viser studie.
Å ha minst ett levende søsken eller høy utdanning har beskyttende effekt, viser studien som er publisert i American Journal of Geriatric Psychiatry. – Vi ventet oss at de kognitive funksjonene skulle påvirkes negativt av å bli enke eller enkemann, men den beskyttende effekten av å ha et søsken i live og høyere utdanning fascinerte oss, sier Giyeon Kim som er en av forskerne bak studien. (NTB)

Den nye, offentlig finansierte apotektjenesten
Medisinstart er endelig en realitet.
Men Farmasiforbundet er skuffet over manglende involvering, og er bekymret for gjennomføringsevnen.
Av: Kristin Rosmo
Medisinstart som en offentlig finansiert apotektjeneste har vært en realitet siden 2. mai. Det gleder både politikere, en samlet apotekbransje og hjertepasienter. Stortinget har i år satt av fire millioner kroner til gjennomføringen. Med en offentlig finansiering på 225 kroner per oppfølgingssamtale rekker budsjettet til nesten ni tusen pasienter ut året. Myndighetene skal evaluere tjenesten før det tas en beslutning om å innføre tjenesten permanent.
Det har vært en lang prosess fra en slik tjeneste ble nevnt i Legemiddelmeldingen fra 2015, fram til i dag. Apotekforeningen og Apokus har blant annet gjennomført en forskningsstudie på 1500 pasienter for å dokumentere effekten av Medisinstartsamtaler med apotekfarmasøyt.
Vil utnytte farmasøytkompetansen
Statssekretær i Helse- og omsorgsdepartementet, Line Miriam Sandberg, sto for det offisielle startskuddet med snorklipping under Apotekforeningens Medisinstart-markering 2. mai. – Medisinstart er en konkret oppfølging av Legemiddelmeldingen. Feil bruk av legemidler er en av de største utfordringene i helsetjenesten. Ikke minst er manglende etterlevelse et stort problem, spesielt blant kronisk syke, sier statssekretæren.
Internasjonal forskning viser at mellom en tredjedel og halvparten av pasientene bruker legemidlene sine feil. Andre avslutter behandlingen. I Norge dør mellom 1000 og 2000 personer årlig av feil legemiddelbruk.
– Det er viktig at flere enn legen kan gi informasjon om riktig legemiddelbruk. Regjeringen mener at andre helsepersonellgrupper kan og bør bidra. Farmasøyter har en helhetlig kompetanse og en viktig rådgiverrolle, og denne kompetansen kan utnyttes enda bedre, sier Sandberg.

Publikumsbrosjyre om Medisinstart. Foto: Kristin Rosmo.

Apotektekniker Lina Tylden og apoteker Johan Stensson ved Vitusapotek Elverum har begge startet med sine respektive oppgaver knyttet til den nye apotektjenesten Medisinstart. Foto: Vitusapotek Elverum.
Hun poengterte videre at apotek er et lavterskeltilbud som har gode forutsetninger for å kunne gjennomføre en slik viktig oppgave. Sandberg tror Medisinstart vil bidra til en bedre utnyttelse av samfunnets ressurser.
Farmasiforbundet skuffet
– At apotekene endelig kan tilby den offentlig finansierte apotektjenesten Medisinstart, er i utgangspunktet svært gledelig. Men jeg er skuffet over at apotekteknikere ikke er involvert i arbeidet med å utforme eller gjennomføre tjenesten, sier Farmasiforbundets leder, Irene Hope.
Hope understreker imidlertid at hun mener at utviklingen med offentlig finansierte apotektjenester er positiv for bransjen, men liker dårlig at bare halvparten av helsepersonellet på apotek involveres i utøvelsen av tjenesten. – Jeg har en viss forståelse for at politikerne ønsker å bruke farmasøytene til tjenester det offentlige skal betale for. Men jeg tror
bransjen hadde fått en bedre gjennomføringsevne med apotekteknikere på laget.
Hope tror at enkelte apotek kan få store utfordringer med å gjennomføre tjenesten på grunn av manglende farmasøytiske ressurser.
– Dette hadde vært en fin anledning til faglig utvikling for hele personalet. Apotekteknikere er en del av helsepersonellet i apotek, og den samlede kompetansen på apotek må bygges opp hos alt helsepersonell som arbeider der, sier hun.
Hope mener at kompetansen nærmest bygges ned for apoteket som helhet når apotekteknikere utelukkes fra alt som har med Medisinstart å gjøre.
– Vår yrkesgruppe er holdt helt utenfor arbeidet med utvikling av tjenesten, sier hun.
Farmasiforbundets leder trekker også fram tjenesten Inhalasjonsveiledning som et eksempel på en tjeneste apotekteknikere
både var og er klare for å utøve. Hun mener apotekteknikere er genuint opptatt av riktig legemiddelbruk, og at yrkesgruppen har mye å bidra med om også de blir skolert inn mot enkelttjenester, slik farmasøytene nå blir.
Krever farmasøytisk kompetanse Fagdirektør i Apotekforeningen, Per Kristian Faksvåg, diskuterer gjerne kompetanseutvikling og nye oppgaver med Farmasiforbundet. Han mener imidlertid at spesialisert legemiddelrådgivning er en oppgave for farmasøytene.
– Det er bra at lederen i Farmasiforbundet ser verdien av at det innføres nye helsetjenester i apotekene. I tillegg til at Medisinstart er et viktig pasienttilbud, understreker tjenesten apotekenes plass i helsetjenesten og øker sannsynligheten for at pasientene oppsøker apoteket i framtiden. Det er i hele apoteksektorens interesse. Det er også positivt at apotekteknikerne ønsker å bygge opp sin kompetanse, men Medisinstart er en tjeneste
som krever farmasøytisk kompetanse langt utover det man tilegner seg gjennom den målrettede Medisinstart-opplæringen, poengterer han.
Faksvåg viser til at ulik utdanning gir ulike oppgaver i apoteket. Apotekteknikerne har en stor og viktig oppgave å gjøre i kunderådgivning innen blant annet egenomsorg. – Et annet område vi jobber med i Apotekforeningen, er vaksinering i apotek. Der har apotekteknikerne allerede vist at de har en plass, og det vil vi følge opp i vårt utredningsarbeid, sier fagdirektøren.
I gang på Elverum
Ved Vitusapotek Elverum er både apoteker Johan Stensson og apotektekniker Lina Tylden i gang med Medisinstart. – Det har vært så givende å gjennomføre de to samtalene jeg har hatt til nå. I begge tilfellene har det vært pasienten selv som har bedt om tjenesten. Den ene hadde nettopp startet med blodtrykksenkende medisin, og den andre blodfortynnende. Under den ene samtalen avdekket vi en alvorlig interaksjon, og det kunne gått riktig galt om det ikke hadde blitt oppdaget, forteller Stensson.
De tre farmasøytene ved apoteket er alle kvalifiserte tjenestefarmasøyter. I tillegg til apoteker Stensson og de to andre farmasøytene har apoteket tre ansatte apotekteknikere. Stensson har hatt Medisinstart som tema på to personalmøter, slik opplæringspakken fra Apokus angir.
– Ett opplæringsmøte om selve tjenesten, og ett om hvordan vi kan fange opp de pasientene som kan ha nytte av Medisinstart, sier han.
Det er ikke meningen at apotek skal rekruttere pasienter. Apotek skal likevel kunne informere relevante pasienter om tjenesten. Derfor må alle apotekansatte som møter kunder vite hva tjenesten går ut på, og hvem den er relevant for. – Apotekteknikere er ofte de første
kundene møter på apoteket. De må derfor kunne informere om Medisinstart til målgruppen. At apotekteknikerne er oppdatert på tjenesten, er en forutsetning for at Medisinstart skal lykkes som apotektjeneste, sier Stensson.
Godt forberedt
Apotektekniker Lina Tylden har til nå informert et par pasienter om tjenesten. – Den aller første jeg informerte om Medisinstart, var en dame som skulle hente ut blodfortynnende medisin for først gang. Hun var svært skeptisk til å begynne med et slikt legemiddel, spesielt med tanke på bivirkningene. Jeg informerte henne så godt jeg kunne om muligheten for Medisinstart, og hun fikk med seg brosjyren. Hun bodde ikke her i Elverum, men jeg håper at hun har bedt om Medisinstart hos sitt lokale apotek, sier Tylden.
I tillegg til personalmøtene som har omhandlet Medisinstart, mener Tylden at hun har hatt god nytte av kjedens eget opplæringsmateriell om Medisinstart-tjenesten.
– Vi har fått en mal og sett videoer på hvordan vi kan legge fram informasjon om Medisinstart. De har vært gode
å støtte seg på som en del av forberedelsene, sier hun.
Fagdirektør i Apotekforeningen, Per Kristian Faksvåg, mener Medisinstart understreker apotekenes plass i helsetjenesten og øker sannsynligheten for at pasientene oppsøker apoteket i framtiden. Foto: Kristin Rosmo.
Apokus har utviklet opplæringsmateriellet til Medisinstart.
Skisse: Apotekforeningen.
Tilbud til pasienter som begynner ny behandling med et blodtrykkssenkende eller blodfortynnende legemiddel, eller et kolesterolsenkende statin.
· Tjenesten består av to samtaler med en tjenestefarmasøyt,hhv. 1–2 og 3–5 uker etter oppstart med nytt legemiddel.

· Tjenestefarmasøytene må gjennom et bredt opplæringsprogram.
· Tjenesten skal bidra til at pasienten får større forståelse og motivasjon for behandlingen.
· Pasienten kan også få svar på spørsmål om bruken av legemidlene.
· Samtalen skal journalføres.
· Stortinget har satt av fire millioner kroner til gjennomføring av Medisinstart i 2018.
· Tjenesten er gratis for pasientene.
· Tjenesten utføres etter henvisning fra lege eller initiativ fra pasienten selv.
Apotekene får en refusjon på 225 kroner per oppfølgingssamtale. I løpet av mai måned hadde 387 Medisinstart-samtaler funnet sted ved tilsammen 175 apotek.
Kilde: apotek.no, Helfo.no
Modellen under er ment for å hjelpe deg som apotekansatt med å visualisere det store spekteret av halsbrannplager, og kan være til hjelp i møtet med halsbrannkunden.
Be kunden om å beskrive sin halsbrann, avdekk behov, vær oppmerksom på hvilke kunder som ikke er velegnet for egenbehandling og anbefal medikament ut fra egen faglig vurdering.
Kunder med sporadiske symptomer beskriver plagene som milde eller sjeldne.1 Kunder med tilbakevendende symptomer beskriver plager som opptrer med jevne mellomrom (med en viss frekvens).3 Kunder som opplever vedvarende symptomer skal henvises til lege. Denne type symptomer er ikke velegnet for egenbehandling.2

SOMAC Control® er:
• velegnet for kunder med tilbakevendende halsbrann3
• en effektiv protonpumpehemmer for korttidsbehandling av halsbrann og sure oppstøt2
• et legemiddel som hemmer både basal og stimulert syresekresjon1
Somac Control®(pantopraazol). Korttidsbehandling (opptil 4 uker) av reflukssymptomer hos voksne> 18 år. Ikke tas samtidig med andre protonpumpehemmere eller H2-antagonister. Dersom ingen bedring innen 2 uker, ny konsultasjon. Kontraindisert: Ved bruk av hiv-proteasehemmere. Skal ikke brukes ved graviditet eller amming. Administrering: Tas før mat. Svelges hele med vann. Ikke tygges eller knuses. For mer informasjon se Felleskatalogteksten.
Referanser:
1. Assessment report for Somac Control, procedure no. EMA/H/C/001098, London 08.05.2009. http://www.ema.europa.eu/docs/en_GB/document_library/EPAR_-_Public_assessment_report/human/001098/WC500054370.pdf (28.07.2015)
2. SPC SOMAC Control, avsnitt 4.1, 4.2, 4.3, 4.4, 4.6 og 4.8 28.11.16, www.legemiddelsok.no
3. G.Holtmann, M-A. Bigard, P. Malfertheiner et. al. Guidance on the use of over-the-counter proton pump inhibitors for the treatment of GERD. Int J Clin Pharm (2011)33:493-500, figur 1.
Somac Control
Syrepumpehemmer, saltsyresekresjonshemmende middel.
Står ikke på WADAs dopingliste
ENTEROTABLETTER 20mg:Hverenterotablettinneh.:Pantoprazolnatriumsesquihydrat tilsv. pantoprazol 20 mg, mannitol, hjelpestoffer. Fargestoff: Gult, rødt og sort jernoksid (E 172), titandioksid (E 171). Indikasjoner: Korttidsbehandling av reflukssymptomer (f.eks. halsbrann, sure oppstøt) hos voksne. Dosering: Voksne:Anbefalt dose er 20 mg daglig. Det kan være nødvendig å ta preparatet i 2-3 etterfølgende dager for å oppnå symptomlindring. Behandlingen avsluttes ved symptomfrihet. Behandlingsvarighet skal ikke overstige 4 uker uten at lege er konsultert. Dersom ingen bedring oppnås innen 2 ukers kontinuerlig behandling, skal lege kontaktes. Barnogungdom<18år:Ikke anbefalt pga. utilstrekkelige data. Administrering:Tas før mat. Svelges hele med litt vann. Skal ikke tygges. Skal ikke knuses. Kontraindikasjoner: Overfølsomhet for innholdsstoffene. Samtidig bruk av hiv-proteasehemmere. Forsiktighetsregler: Kun beregnet til kortvarig bruk (opptil 4 uker). Pasienten skal advares om tilleggsrisikoer ved langvarig bruk, og behovet for forskrivning og regelmessig overvåkning skal understrekes. Ved utilsiktet vekttap, anemi, gastrointestinal blødning, dysfagi, vedvarende eller blodig oppkast, skal lege kontaktes, da symptomene kan lindres og forsinke diagnosen av alvorlige tilstander. I disse tilfeller skal malignitet utelukkes. Lege skal kontaktes ved tidligere magesår eller operasjon i mage-tarmkanalen, ≥4 ukers kontinuerlig symptomatisk behandling av fordøyelsesplager eller halsbrann, gulsott, nedsatt leverfunksjon eller leversykdom, andre alvorlige sykdommer som påvirker allmenntilstanden, eller dersom pasienten er >55 år med nye eller nylig endrede symptomer. Langvarige periodiske symptomer på fordøyelsesplager eller halsbrann krever regelmessig legekontroll. Andre protonpumpehemmere eller H2-reseptorantagonister skal ikke tas samtidig. Lege skal konsulteres før bruk dersom endoskopi eller ureatest skal utføres. Pantoprazol skal ikke brukes forebyggende. Nedsatt gastrisk surhet øker antall bakterier som normalt er i mage-tarmkanalen. Dette medfører lett økt risiko for gastrointestinale infeksjoner som Salmonella, Campylobacter eller C. difficile. Protonpumpehemmere er forbundet med svært sjeldne tilfeller av subakutt kutan lupus erythematosus (SCLE). Ved lesjoner, spesielt på soleksponert hud, og hvis forbundet med atralgi, bør lege oppsøkes raskt og seponering vurderes. SCLE etter tidligere protonpumpehemmerbehandling kan øke risikoen for SCLE ved bruk av andre protonpumpehemmere. Økt kromogranin A (CgA)-nivå kan forstyrre undersøkelser av nevroendokrine svulster. For å unngå slike forstyrrelser, bør behandling stoppes ≥5 dager før CgA-måling. Dersom CgA- og gastrinnivået ikke er normalisert etter 1. måling, bør målingene gjentas etter 14 dager. Pantoprazol kan redusere absorpsjonen av vitamin B12 ved langvarig bruk. Protonpumpehemmere (PPI), spesielt i høye doser og over lang tid (>1 år), kan i beskjeden grad øke risikoen for fraktur i hofte, håndledd og ryggrad, hovedsakelig hos eldre eller ved andre risikofaktorer. Pasienter med risiko for osteoporose bør få behandling (iht. gjeldende retningslinjer) og tilstrekkelig inntak av vitamin D og kalsium. Alvorlig hypomagnesemi er rapportert hos pasienter behandlet med PPI ≥3 måneder. Alvorlige symptomer kan komme snikende og overses. For de fleste bedrer hypomagnesemien seg etter magnesiumbehandling og seponering av PPI. Måling av magnesiumnivåene bør vurderes før oppstart og periodisk under behandlingen. Interaksjoner: For utfyllende informasjon fra Legemiddelverket om relevante interaksjoner, se A02B C02. Dersom absorpsjonen av et legemiddel er pH-avhengig, kan absorpsjonen endres ved samtidig administrering. Mulighet for interaksjon med legemidler som metaboliseres via CYP450 kan ikke utelukkes. Noen få isolerte tilfeller av endringer i INR er rapportert ved samtidig bruk av fenprokumon eller warfarin. INR skal kontrolleres ved samtidig bruk av kumarinantikoagulantia etter oppstart, seponering eller ved uregelmessig bruk av pantoprazol. Ved samtidig bruk av høydose metotreksat (f.eks. 300 mg) og protonpumpehemmere er økte metotreksatnivåer hos noen pasienter rapportert. Ved bruk av høydose metotreksat (f.eks. kreft og psoriasis), kan derfor midlertidig seponering av pantoprazol vurderes som nødvendig. Graviditet, amming og fertilitet: Graviditet:Ingen data. Dyrestudier har vist reproduksjonstoksiske effekter. Potensiell human risiko er ukjent. Skal ikke brukes under graviditet. Amming:Pantoprazol/metabolitter går over i morsmelk. Effekt på nyfødte/spedbarn er ukjent. Skal ikke brukes under amming. Bivirkninger: Ca. 5% av pasientene får bivirkninger. Vanlige (≥1/100til <1/10):Gastrointestinale: Kjertelpolypper i ventrikkelen (benigne). Mindrevanlige(≥1/1000til <1/100):Gastrointestinale: Diaré, kvalme, oppkast, oppblåsthet, forstoppelse, munntørrhet, magesmerte og ubehag. Hud: Utslett, eksem, erupsjon, pruritus. Lever/galle: Økte leverenzymer (transaminaser, γ-GT). Muskel-skjelettsystemet: Fraktur i hofte, håndledd eller ryggrad. Nevrologiske: Hodepine, svimmelhet. Psykiske: Søvnforstyrrelser. Øvrige: Asteni, tretthet, utilpasshet. Sjeldne(≥1/10000til<1/1000):Blod/lymfe: Agranulocytose. Hud: Urticaria, angioødem. Immunsystemet: Hypersensitivitet (inkl. anafylaktiske reaksjoner og anafylaktisk sjokk). Kjønnsorganer/bryst: Gynekomasti. Lever/galle: Bilirubinøkning. Muskel-skjelettsystemet: Artralgi, myalgi. Nevrologiske: Smaksforstyrrelser. Psykiske: Depresjon (og forverring). Stoffskifte/ernæring: Hyperlipidemi, lipidøkning (triglyserider, kolesterol), vektforandringer. Øye: Synsforstyrrelser, uklart syn. Øvrige: Økt kroppstemperatur, perifert ødem. Sværtsjeldne(<1/10000) ukjent: Blod/lymfe: Trombocytopeni, leukopeni, pancytopeni. Hud: Stevens-Johnsons syndrom, Lyells syndrom, erythema multiforme, fotosensitivitet, subakutt kutan lupus erythematosus. Lever/galle: Hepatocellulær skade, gulsott, leversvikt. Nyre/urinveier: Interstitiell nefritt. Psykiske: Desorientering (og forverring), hallusinasjoner, forvirring (særlig hos disponerte pasienter og forverring av eksisterende symptomer). Stoffskifte/ernæring: Hyponatremi, hypomagnesemi. Overdosering/Forgiftning: Symptomer:Ingen kjente. Doser opptil 240 mg gitt i.v. i løpet av 2 minutter ble godt tolerert. Behandling:Symptomatisk og støttende. Pantoprazol er ikke dialyserbart pga. høy proteinbinding.Egenskaper: Klassifisering:Protonpumpehemmer. Pantoprazol er et substituert benzimidazol som doseavhengig hemmer saltsyresekresjon i magesekken via spesifikk blokade av parietalcellenes protonpumpe. Virkningsmekanisme: Pantoprazol omdannes til aktiv form, et syklisk sulfenamid, i parietalcellenes sure miljø hvor det hemmer H+, K+-ATPasen. Hemmer både basal og stimulert saltsyresekresjon. Pantoprazol gir økt pH i ventrikkelen og dermed økt gastrinproduksjon. Gastrinøkningen er reversibel og proporsjonal med syrereduksjonen. Pantoprazol binder til enzymet distalt for reseptornivået og påvirker saltsyresekresjonen uavhengig av type stimulus (acetylkolin, histamin, gastrin). De fleste pasientene oppnår lindring av halsbrann og reflukssymptomer på 2 uker. Absorpsjon: Fullstendig og raskt. Biotilgjengelighet er ca. 77 % og hverken AUC eller Cmax påvirkes av samtidig matinntak. Forsinkelse av absorpsjonen kan derimot oppstå. Cmax (1-1,5 μg/ml) nås ca. 2-2,5 timer etter administrering av en enkeltdose på 20 mg. Endres ikke ved gjentatt dosering. Proteinbinding:Ca. 98 %. Fordeling:Vd: Ca. 0,15 liter/kg. Halveringstid: Ca. 1 time. Metabolisme:Nesten utelukkende i leveren. Utskillelse:Metabolittene utskilles primært renalt (80%), resten via feces. Pakninger uten resept: Enterotabletter 7 stk. og 14 stk. er unntatt fra reseptplikt. Sist endret: 02.06.2017
Ta kontakt på tlf: 800


Inneholder både klorheksidin og fluor
Flux PRO Klorhexidin Skyll
0,12% Klorheksidin
0,2% NaF
0% Alkolhol

Smak av Coolmint
Flux PRO Klorhexidin inneholder både klorheksidin og fluor. Produktene er for kortidsbehandling eller etter anbefaling fra tannhelsepersonell. Som øvrige Flux produkter er de uten alkolhol og parabener. Utviklet i samarbeid med skandinavisk tannhelse.
Dosering:
Voksne og barn over 12 år: Brukes 1–2 ganger daglig i inntil to uker eller etter anbefaling fra tannhelsepersonell. Skyllen har en praktisk doseringspumpe som gir riktig dosering hver gang.
Flux PRO Klorhexidin Gel
0,12% Klorheksidin
1000 ppm F
0% Alkohol
Smak av Coolmint
Har du fluxet i dag?
De nye reglene for pasientjournal gjelder også for apotekansatte. Forskriften er på høring denne sommeren og skal deretter følges opp med en ny forskrift som vil definere nærmere hvordan apotekene skal håndtere helseopplysninger.
Av Magne Otterdal
Helse- og omsorgsdepartementet sendte våren 2018 ut på høring forslag til ny forskrift om pasientjournal.
– I motsetning til dagens pasientjournalforskrift foreslår departementet å gjøre den nye forskriften gjeldende for personell i apotek, skriver departementet i innledningen til høringsdokumentet.
Én innbygger – én journal
Dermed er nok et steg tatt i retningen av målet om «én innbygger – én journal», beskrevet i stortingsmelding 9 som daværende helseminister Jonas Gahr
Støre fremla i 2013. Arbeidet har pågått siden, og fra 2016 er utviklingen styrt av Direktoratet for e-helse.
Lover og regler revideres og høres for å skape rammeverket for fellesjournalen,
derfor også forslaget til ny pasientjournal. Alle som yter helsehjelp har plikt til å føre journal, dermed også de apotekansatte.
Ifølge leder Irene Hope i Farmasiforbundet betyr ikke denne forskriften at hennes 3500 medlemmer vil få endret sine arbeidsoppgaver i praksis. – Forskriften får ikke direkte konsekvenser for oss, sier Hope til Farmasiliv.
Hun peker på at pasientjournalforskriften betyr at apotekene nå er implementert som helsevirksomheter.
Det handler ikke om nye oppgaver, det betyr at apotekene skal bli journalføringspliktige. Det Hope er opptatt av, er den påfølgende forskriften som nærmere
vil definere arbeidsoppgavene knyttet til journalføring i apotekene. Departementet varsler nemlig et eget forslag til hva som anses å være en integrert del av reseptekspedisjonen og kravene til dokumentasjon etter apotekloven paragraf 5-5a, i en egen høring.
Integrering og autorisering
Den nye pasientjournalforskriften innebærer integrering og autorisering av funksjonene i apotekene som en del av helsesektoren. Alle som jobber i apotek er definert som helsepersonell.
Den nye forskriften erstatter to forskrifter for håndtering av personlige helseopplysninger i Norge: Forskrift av 21. desember 2000 nummer 1385 om pasientjournal og forskrift av 17. desember 2014 nummer 1757 om tilgang til helseopplysninger mellom virksomheter. Ifølge departementet følger endringen opp grunntanken i stortingsmelding 9 (2012–2013) «Én innbygger – én journal». – Helsepersonell skal ha rask og effektiv tilgang til nødvendige og oppdaterte

Farmasiforbundets leder Irene Hope vil følge nøye med når en ny forskrift om reseptekspedisjon og krav til dokumentasjon fremlegges. Det er her det eventuelt kan bli endringer i de daglige rutinene på apoteket. Foto: Vetle Daler.
pasientopplysninger, samtidig som personvernet ivaretas. Dette gjelder gjennom hele behandlingsforløpet, uavhengig av hvor i landet pasienten blir syk eller får behandling, heter det i høringsdokumentet.
Helse- og omsorgsdepartementet antyder at det norske «pasientopplysningsuniverset» fortsatt har et stykke å gå før et felles system er på plass. Pasientens journalopplysninger ligger fortsatt lagret i mange ulike elektroniske systemer og i ulike virksomheter.
Felles systemer
Ifølge departementet samarbeider virksomhetene i større grad om felles systemer for elektronisk pasientjournal, laboratorieog røntgensystemer og andre fagsystemer. – I de regionale helseforetakene har det over flere år pågått et betydelig konsolideringsarbeid, slik at sykehusene i flere av regionene nå i hovedsak har felles IKTsystemer, skriver departementet i innledningen til pasientjournalforskriften.
Det er også etablert nasjonale e-helseløsninger, blant annet kjernejournal, e-resept og digitale innbyggertjenester på helsenorge.no, nettstedet som gjør tilgjengelig helseopplysninger for den enkelte pasient.
3,5 millioner fikk legemiddel på resept Legemidler er en viktig innsatsfaktor både til forebygging og behandling. Data fra reseptregisteret viser at om lag 3,5 millioner nordmenn, det vil si 69,3 prosent av den norske befolkningen, fikk utlevert minst ett legemiddel på resept i løpet av 2016.
– Helsehjelp som ytes i apotek, har tradisjonelt blitt ansett å ha en annen karakter enn helsehjelp som ytes i andre typer helsetjenester, heter det i forskriftsforslaget.
Dokumentasjonsplikten etter apoteklovens paragraf 5-5 a omfatter all ekspedisjon og utlevering av legemidler og handelsvarer etter resept og rekvisisjon. Departementet mener det er naturlig at de bestemmelser som utdyper journalføringsplikten for personell som yter helsehjelp i apotek, følger de samme reglene som gjelder for helsepersonell som yter helsehjelp i andre virksomheter.
– Departementet foreslår derfor at helsehjelp i apotek skal omfattes av den nye pasientjournalforskriften.
Egen høring om reseptekspedisjon En reseptekspedering er en kontroll og istandgjøring av et legemiddel i henhold til en resept. Når dette er gjort, utleveres legemidlet til pasienten. Departementet

anser at ekspedering av legemiddel faller inn under definisjonen av helsehjelp, noe som er omtalt i helsepersonellovens paragraf 3.
Dette gjelder selv om ekspederingen ikke innebærer helsemessige vurderinger utover det som allerede er gjort av forskrivende lege. Veiledning og råd som er individuelt tilpasset av behandlingsrettet karakter og basert på informasjon som pasienten gir fra seg, må også anses som helsehjelp. Det samme gjelder vurdering av interaksjoner, intervensjoner og nødekspedisjoner som gjøres i apotek.
– Råd av mer uforpliktende og generell karakter og som ikke er tilpasset den enkelte, kan imidlertid ikke anses for å være dokumentasjonspliktig helsehjelp, heter det i forskriften.
Tjenester som innebærer individrettet oppfølging eller behandlingstilbud, basert på kunnskap om den enkelte pasient, kan imidlertid være helsehjelp. For eksempel kan oppstartsveiledning i apotek etter departementets oppfatning være helsehjelp. En slik tjeneste må ofte være basert på kunnskap om og være tilpasset den aktuelle pasienten.
Videre vil den inneholde en individuell faglig vurdering som er av en kvalifisert
handlingsrettet karakter.
– Departementet vil komme med forslag til hva som anses å være en integrert del av reseptekspedisjonen og kravene til dokumentasjon etter apoteklovens paragraf 5-5a i egen høring, heter det i forslaget til pasientjournalforskrift.
Følger nøye med
Det er denne høringen apotekteknikerne er særlig opptatt av, bekrefter forbundsleder Irene Hope.
– Vi kommer til å følge nøye med på det som skjer videre, og hva det innebærer, sier Hope.
Hun opplever det som skjer som en naturlig utvikling i retning én innbygger, én journal.
– Nå får vi verktøyet vi trenger til å gi en god legemiddelgjennomgang og informasjon til pasienten. Vi får bedre samhandling med andre helseinstanser som leger og sykehus, sier Hope.
Apotekene har lovpålagte krav til dokumentasjon av reseptekspedisjon, som omfatter all ekspedisjon av og utlevering av legemidler etter resept og rekvisisjon. Dokumentasjonsplikten skal sikre kvaliteten av reseptkontroll og pasientveiledning, mulighet for i ettertid å kunne spore hva

som ble ekspedert, og bruk av ekspedisjonsdata i forbindelse med tilsyn med rekvirenter.
Helseminister Bent Høie utpekte MidtNorge som nasjonal utprøvingsarena for fellesjournalen. Det startet i 2015 da Helse Midt-Norge igangsatte prøveprosjekt ved St. Olavs hospital i Trondheim. I 2017 ble det videreført i prosjektet «Helseplattformen» i regi av Helse MidtNorge og Trondheim kommune. Alle kommuner i regionen har mulighet til å delta.
Etter planen skal leverandør av teknologi til driften av helseplattformen være på plass i 2019. Så langt har nesten 400 helse- og IKT-medarbeidere vært involvert

Etter fem år begynner den nye fellesjournalen å ta form som «Helseplattformen» i Midt-Norge. Helseminister Bent Høie sier journalen gir både pasienter og helsearbeidere «fantastiske muligheter», men han peker også på den høye risikoen med prosjektet.
i planlegging og workshops.
– Det er veldig spennende å følge arbeidet. Mange av erfaringene en høster i Midt-Norge bruker vi i det nasjonale arbeidet, sier helseminister Bent Høie i et YouTube-intervju i mars 2018.
Ifølge Høie vil det være i Midt-Norge en vil se innføringen av «én innbygger – én journal». Han peker på mulighetene journalen vil gi både pasientene og de tusenvis som jobber i helsetjenesten.
Han peker samtidig på risikoen med et slikt prosjekt.
– Slike prosesser har høy risiko. Det er komplisert. Når man tar i bruk nye verktøy, er det ikke alltid at alt fungerer 100 prosent fra dag én. Vi må være forberedt på noen humper i veien, sier Bent Høie.
Utdanningsdirektoratet og Faglig råd for helse- og oppvekstfag (FRHO) har sammen med blant annet Farmasiforbundet og Tannhelsesekretærenes Forbund (ThsF) jobbet for å utvikle kvaliteten i utdanningen av helse- og oppvekstfagene på videregående nivå. Det skal de fortsette med.
Av: Amalie Solnørdal Nærø
En av dem som har jobbet med denne problemstillingen, er leder i Faglig råd for helse- og oppvekstfag, Tonje Thorbjørnsen. Faglig råd og Utdanningsdirektoratet har anbefalt at både apotekteknikere, tannhelsesekretærer og helsesekretærer skal få anledning til å spesialisere seg, eller kunne velge fordypning, allerede på Vg2.
– Vi hadde i forkant sett på om det var mulig for egne Vg2 for disse tre fagene, men konklusjonen ble at det ville kunne få negative konsekvenser, blant annet for få søkere, slik at linjen dermed kunne blitt lagt ned ved enkelte skoler, sier Thorbjørnsen.
Dermed endte Faglig råd og Utdanningsdirektoratet opp med å foreslå innføring av såkalt yrkesfaglig fordypning i yrket på Vg2. Tanken er at de som vet at de vil bli apotekteknikere, kan bruke avsatte timer til fordypning i sitt fag.
Kunnskapsdepartementet sa nei
Forslaget var ute på høring sammen med de øvrige endringsforslagene til ny tilbudsstruktur, men
Kunnskapsdepartementet valgte å ikke anbefale en slik ordning. I stedet skal man se på muligheten for å innføre såkalt yrkesfaglig fordypning (YFF) på Vg2 helseservice. Disse timene kan brukes til praksis eller fordypning i de enkelte yrkesfagene.

– Men dette blir frivillig fra skolenes side. Jeg spurte Kunnskapsdepartementet om hvorfor man ikke ønsket en ordning for å sikre mer faglig spesialisering, og svaret var at det er snakk om for små fag, med for få elever til å gjøre så store steg. Jeg synes vel ikke det er et godt argument, fordi forslagene var enstemmige i fagmiljøet og blant partene, sier Thorbjørnsen.
Et annet forslag var å få på plass et system for obligatorisk praksis for de tre yrkeskompetansefagene. Dette mente også Kunnskapsdepartementet ville bli for vanskelig.
– Igjen blir det opp til skolene og hvor flinke de er til å knytte kontakter med virksomheter i nærmiljøet, sier Thorbjørnsen.
Thorbjørnsen mener at yrkeskompetansefagene får litt mindre oppmerksomhet enn fagopplæringsfagene.
– De får mindre oppmerksomhet fordi det er få av dem. Det blir en slags skjevhet der. Samtidig fungerer fagene greit, så det ses ikke på som et problem for Kunnskapsdepartementet, sier hun.
Hun sier Faglig råd for helse- og oppvekstfag ikke har tenkt til å gi seg. I stedet for å hamre løs på en løsning som ikke kommer noen vei, mener Thorbjørnsen det

Nestleder i Farmasiforbundet, Bodil Røkke, er skuffet over at det ikke ble noe av tidligere spesialisering for elevene. Arbeidet med læreplannivå blir viktig. Foto: Parat.

Kunnskapsdepartementets synspunkt om at det er snakk om for små fag, med for få elever til å gjøre så store steg, mener leder i Faglig råd for helse- og oppvekstfag, Tonje Thorbjørnsen, ikke er noe godt argument. Hun peker på at forslagene var enstemmige i fagmiljøet og blant partene.

kan være lurt å se på andre løsninger.
– Det kan kanskje være å forsøke noen pilotprosjekter eller annet som kan drive fagutviklingen fremover.
Faglig råd har ikke glemt disse fagene, selv om forslagene ble avslått. Og rådet vil selvsagt fortsette å samarbeide med fagmiljøene. Ikke minst blir det viktig i utviklingen av nye læreplaner, sier hun.
Farmasiforbundet skuffet
I dag har apotekteknikere, tannhelsesekretærer og helsesekretærer felles videregående opplæring, frem til det tredje året der de skilles. Nestleder i Farmasiforbundet
Bodil Røkke er skuffet over at det ikke ble noe av tidligere spesialisering for elevene.
Hun mener de to første årene er viktig for at elevene kan spesialisere seg i det de ønsker, og derfor blir arbeidet med læreplannivå viktig fremover. – Nå er strukturen er satt, så vi må jobbe med læreplanen som skal lages i høst. Det er vel så viktig. Vi samarbeider tett med både tannhelsesekretærene og helsesekretærene om dette, sier Røkke.
De tre fagene har felles interesser. Sammen skal de gå gjennom dagens læreplaner og se om noe bør fjernes, og om noe bør legges til.
Lovpålagt praksis og nasjonale eksamensoppgaver Røkke ønsker også at det skal være et krav om praksis og nasjonale eksamensoppgaver. I dag er det opp til hver enkelt fylkeskommune å lage eksamenssett. –Vi ser at eksamenssettene blir preget av lokale interesser og hva lærerne på hver enkelt skole er opptatt av. Vi ønsker et mer overordnet eksamenssett, slik at elevene får den samme kunnskapen, uansett hvor de fullfører eksamen, sier Røkke.
I tillegg er det nedsatt et utvalg, Liedutvalget, som skal se på den helhetlige videregående opplæringen. Utvalget skal blant annet komme frem til styrker og svakheter ved dagens videregående opplæring. Deretter skal de komme med forslag til endringer i struktur, organisering og fagsammensetning. Den første innstillingen skal leveres i slutten av 2018.
Røkke skal delta på en innspillkonferanse som utvalget arrangerer.
– Der kommer vi til å jobbe med å få mer dybdekunnskap i apotektekniker-, tannhelsesekretær- og helsesekretærfagene, sier Røkke.
Apotektekniker Tigist Lule fikk en uforglemmelig tur til hjemlandet med Farmasøyter uten grenser. Kompetanse i kombinasjon med å beherske det etiopiske språket amharisk førte henne til Black Lion Hospital i Addis Abeba i oktober i fjor.
Tekst: Vetle Daler
Tigist Lule (36) er apotektekniker og jobber ved sykehusapoteket på Radiumhospitalet i Oslo. Her arbeider hun blant annet med å lage cytostatikablandinger til kreftpasienter.
Cytostatikaproduksjon
– Det begynte med at jeg reiste på ferie til hjembyen min Addis Abeba i 2016. Mens jeg var der, ble jeg kontaktet av Farmasøyter uten grenser (FUG), som lurte på om jeg kunne være interessert i å bidra i deres arbeid, sier Tigist Lule.
Det ble bare tid til et lite besøk på Black Lion Hospital den gangen, men et år senere var hun tilbake, denne gang i FUGs tjeneste. Oppgaven var å lære opp sykepleierne ved sykehuset i cytostatikaproduksjon.
– Studenter fra farmasøytutdanningene i Oslo, Tromsø og Namsos hadde samlet inn penger til to benker som brukes til å blande cytostatika, og Black Lion er det første sykehuset i Etiopia som bruker denne typen utsyr, sier Tigist Lule.
Mangler utstyr
I to uker holdt hun kurs i bruk av benkene, sammen med Wendy Klem, tidligere apoteker ved Radiumhospitalet og mangeårig engasjert i Farmasøyter uten grenser. – Sykehusene i Etiopia er helt annerledes enn Norge, de mangler mye utstyr for å gjøre jobben sin. Black Lion Hospital er faktisk det eneste sykehuset i Etiopia som behandler kreftpasienter, men det finnes nå planer for flere kreftsentere i landet, sier Lule.
Vil tilbake
Etiopia har en befolkning på nærmere 100 millioner. WHO estimerer ifølge FUG at Etiopia har 120 000–150 000 nye krefttilfeller årlig. Kun 2–3 prosent av pasientene får hjelp av en kreftlege. Dødeligheten er nærmere 80 prosent.
Tigist Lule er glad for å kunne bidra til at kreftbehandlingen i landet blir bedre. – Jeg prøvde å gi alt jeg kunne mens jeg var der. Det er en glede å kunne dele min kunnskap. På den andre siden er det trist å se at de mangler så mye, sier Tigist Lule.
Hun er ikke i tvil om at hun gjerne reiser tilbake hvis muligheten byr seg.
– Hvis de klarer å skaffe til veie flere benker, reiser jeg gjerne tilbake for å drive opplæring.
Yngre krefter
Wendy Klem, som har gjennomført en rekke Etiopia-reiser for FUG, har bare lovord å komme med om Tigists innsats.
– Det var fantastisk å ha henne med til Etiopia, særlig fordi hun snakker amharisk, sier Wendy Klem.
Hun sier Tigist er en veldig flink apotektekniker, og de to ble kjent da de jobbet sammen på Radiumhospitalet. Klem er nå pensjonist, men fortsetter å engasjere seg i FUG.
– Noe av det viktigste for meg nå er at yngre krefter skal engasjere seg i dette arbeidet, sier Wendy Klem.
Oppfordrer til å støtte Farmasøyter uten grenser samarbeider med Oslo universitetssykehus, og Tigist Lule er glad for støtten fra arbeidsgiver.
– Det er godt å vite at jeg har støtte for dette på jobben, derfor fikk jeg permisjon med lønn for å reise, sier Tigist Lule.
Hun oppfordrer alle til å støtte FUGs arbeid, enten ved å bidra med penger eller ved å engasjere seg personlig.
– De trenger flere som kan bidra slik som jeg gjorde, sier hun.
Farmasøyter uten grenser
Farmasøyter uten grenser Norge (FUG Norge) ble stiftet i 2005 og er en nonprofit-organisasjon som er basert på frivillighet.
FUG Norge er del av det internasjonale nettverket Pharmaciens Sans Frontières (PSF)
Organisasjonen oppgir at de arbeider for at alle, uavhengig av økonomi og bosted, får de medisinene de har behov for, når de har behov for dem, og at de er virksomme og sikre når de tas i bruk. De er hovedsakelig involvert i langsiktige prosjekter der overføring av farmasøytisk kompetanse er hovedtema, særlig til helsepersonell i utviklingsland.
FUG Norge har prosjekter i Etiopia, Ghana, Mali og Zambia.
Vil du støtte FUGs prosjekter i Etiopia? Vipps til 12310 og skriv «Etiopia» i meldingsfeltet.




– Det er en glede å kunne dele min kunnskap, sier apotektekniker Tigist Lule. Foto: Vetle Daler

Navn: Tigist Lule
Alder: 36
Bosted: Haugenstua i Oslo
Familie: Gift
Arbeidssted: Sykehusapoteket ved
Radiumhospitalet
Stilling: Apotektekniker
Utdanning: Apotekteknikerlinja ved Bamble vgs. (2004).

Når du er sykemeldt, har arbeidsgiver plikt til å følge deg opp. Men du har også selv plikter under sykefraværet.
Av Ann-Karin Berggren, hovedtillitsvalgt i Apotek1
Under et sykefravær har arbeidsgiver plikt til å følge opp den sykemeldte. Formålet er å hindre unødig langt fravær. Som sykemeldt har du imidlertid selv en «medvirkningsplikt» for at oppfølgingsarbeidet skal bli så bra som mulig, og at du kan komme tilbake på jobb raskest mulig.
Loven er tydelig
Det forekommer en del usikkerhet om hvordan man selv skal medvirke i sykefraværsprosessen. Lovverket er i dette tilfelle tydelig, og du som ansatt er pliktig til å medvirke i sykefraværsprosessen. Dette betyr at du må delta på møter som arbeidsgiver kaller inn til (hvis du ikke har gyldig grunn til ikke å stille). Du skal aktivt samarbeide for å finne løsninger for å komme tilbake i arbeid, og du skal delta i utarbeidelsen av oppfølgingsplanen i samråd med din leder. Dette på samme måte som arbeidsgiver plikter å tilrettelegge for deg, så langt det lar seg gjøre.
Hovedtillitsvalgt i Apotek1 Ann-Karin Berggren. Foto: Vetle Daler
Arbeidsmiljøloven lister opp at arbeidstaker skal:
• melde fra til arbeidsgiver dersom arbeidstaker blir skadet i arbeidet eller pådrar seg sykdom som arbeidstaker mener har sin grunn i arbeidet eller forholdene på arbeidsstedet (paragraf 2-3)
• medvirke ved utarbeiding og gjennomføring av oppfølgingsplaner når du er helt eller delvis borte fra arbeidet på grunn av ulykke, sykdom, slitasje eller lignende (paragraf 2-3)
• delta i dialogmøter ved sykefravær etter innkalling fra arbeidsgiver (paragraf 4-6)
Restarbeidsevne
Det kan også tenkes at arbeidsgiver vil være forpliktet til å omrokere noe på arbeidsoppgavene til de arbeidstakerne som er friske, og således kunne tilby passende arbeid til den sykemeldte.
I den grad det er mulig, har den sykemeldte også en plikt til å utføre arbeid i stedet for å gå hjemme og heve sykepenger. Tanken er at det dels er økonomisk uforsvarlig ikke å utnytte arbeidstakers restarbeidsevne, dels at sykemeldte lettere kommer tilbake i fullt arbeid dersom kontakten med arbeidslivet opprettholdes.
Jobbe sammen
Det er viktig å huske at arbeidsgiver og arbeidstaker sammen skal jobbe for gode arbeidsforhold. En meningsfylt jobb, med gode kollegiale relasjoner og et godt arbeidsmiljø, legger grunnlaget for friske medarbeidere i sunne og produktive arbeidsmiljøer.


aminoJern er et lavdose jerntilskudd som er snill mot magen og samtidig gir et svært godt opptak. Man kan ta det til måltider og sammen med all type mat uten at effekten reduseres. aminoJern inneholder verken gluten, sukker, melk eller noen animalske ingredienser.
aminoJern er tilgjengelig hos Vitus/Ditt Apotek og via NMD.
Les mer på aminojern.no For prøver, brosjyrer og oversikt over studier, send mail til ralph@vitalkost.no eller ring 33 00 38 76.
Etter åtte år i hjemmesykepleien på Oppdal hadde Therese Flotten Volden behov for en endring i arbeidssituasjonen. Med begrensede valgmuligheter fant sykepleieren sin plass på apoteket i fjellbygda.
«Apotekmedarbeider og sykepleier» står det på navneskiltet Therese Flotten Volden bærer på jobb.
– Det er en super kombinasjon, og jeg stortrives på apoteket, sier sykepleieren.
Hennes hjemplass, Oppdal, er den sørligste kommunen i Trøndelag fylke. Kommunen huser rundt syv tusen innbyggere og er dessuten en stor hyttekommune. Industri, med blant annet Oppdalskiferen, og fjellturisme er viktige næringer for kommunen. I høysesongen blir innbyggertallet tre–firedoblet.
– Jeg kjente blant annet på at turnusjobbingen var vanskelig å kombinere med familielivet. Så da Oppdals eneste apotek, Vitusapotek Oppdal, utlyste en ledig 40-prosentstilling som apotekmedarbeider/apotektekniker, søkte jeg – og fikk jobben.
Hun vinket hjemmesykepleien farvel og fant sin plass på apoteket ganske umiddelbart.
– Etter hvert har stillingsstørrelsen fordoblet seg. Jeg inngår nå i et bra lag som består av tre apotekmedarbeidere, en apotektekniker, fire farmasøyter og to sykepleiere.

Flotten Volden valgte sykepleierutdanningen fordi hun er et omsorgsmenneske, og fordi hun liker å arbeide med mennesker.
– Dette er sider ved meg selv jeg til de grader får brukt her på apoteket også. Jeg har dessuten oppdaget at jeg er veldig glad i salg.
Sykepleieren er både logistikk- og markedsansvarlig på apoteket. Hun og kollegene vet å trekke på hverandres faglige kompetanse.
– Jeg har stor nytte av både den apotektekniske og farmasøytfaglige kompetansen hos kollegene mine. Og jeg tror at også de drar nytte av min erfaring med praktisk
sykepleie innen sår, stomi, kateterisering og ernæring.
Hun sier at det er et godt arbeidsmiljø ved apoteket, og at de finner på mye moro.
– Her finner vi stadig sko som har byttet plass i garderoben eller morsomme lapper som umerkelig blir festet på ryggen av apotekjakken. Når slikt skjer, er det ofte samme kollega som står bak. Som hovedmistenkt blir hun utsatt for mange rampestreker til gjengjeld. Hun finner på mye rart og spriter opp stemningen både titt og ofte.
Når Flotten Volden ikke er på jobb, går det stort sett i ett med familieliv. Familien har nylig flyttet inn i et nybygd hus, og begge barna driver aktivt med skiskyting. Hun bruker også gjerne skiene selv, men holder en knapp på langrenn fremfor å stå på ski i det store og flotte alpinanlegget Oppdal er så kjent for.
– Sommerstid er det et hav av fjelltopper å bestige, og jeg bor midt i et eldorado for tur og natur, sier Therese Flotten Volden.
Navn: Therese Flotten Volden
Alder: 42
Bosted: Oppdal sentrum
Familie: Gift og har barna Nora (15) og David (13)
Interesser: Familie, venner, fjellturer
Utdanning: Sykepleier ved Høgskolen i Innlandet (2000)
Arbeidssted: Vitusapotek Oppdal
Arbeidsoppgaver: Logistikk- og markedsansvarlig
Fagorganisert: Ja (Farmasiforbundet)

Stortingsrepresentant og leder av Europabevegelsen, Heidi Nordby Lunde (H), mener et europeisk arbeidsmarkedsbyrå er et skritt i riktig retning. Foto: Hans Kristian Thorbjørnsen.
Byråets arbeidsoppgaver blir å takle utfordringene i et voksende arbeidsmarked som krysser nasjonale landegrenser. Det betyr at byrået skal gi informasjon om de rettigheter arbeidstagere og selvstendig næringsdrivere har om de arbeider i et annet medlemsland.
En annen arbeidsoppgave er å støtte samarbeid mellom nasjonale myndigheter og sikre at EUs felles regler forstås og håndheves på en rettferdig og effektiv måte på tvers av bransjer.
Grenseoverskridende inspeksjoner
Det er også meningen at byrået skal gjennomføre felles grenseoverskridende inspeksjoner med nasjonale myndigheter for å forhindre svindel og misbruk. Dessuten skal byrået mekle og legge til rette for løsninger av grensekryssende tvister. Dette kan blant annet skje hvis et selskap setter i verk omstruktureringer eller masseoppsigelser som rammer ansatte i flere land i Europa.
Årsaken til EUframstøtet er en stadig stigende misnøye innen EUlandene om at unionen er tynget av stor arbeidsløshet,

sosial dumping, arbeidslivskriminalitet og tyngende fattigdom. Det er lenge krevd tiltak som kan få bukt med disse problemene. Ifølge EUlederne skal arbeidsmarkedsbyrået være et skritt på veien. Nå vil EUkommisjonen ifølge NTB følge opp med et formelt lovforslag.
Vedum krever veto
Det gikk ikke mange dager etter signalene kom fra Brussel før debatten tok seg opp i Norge. En av dem som varsler kamp mot det nye byrået, er senterpartileder Trygve Slagsvold Vedum. Han mener at regjeringen i dette tilfellet må bruke sin vetorett.
– Det norske arbeidsmarkedet fungerer i hovedsak meget bra, og det er ingen grunn til at vi skal gi fra oss kontrollen over det. Ingen aktører på det norske arbeidsmarkedet ønsker EU inn, sier Vedum til Klassekampen.
Heller ikke lederen i Nei til EU, Kathrine Kleveland, er begeistret for EUs nye framstøt på det europeiske arbeidsmarkedet. – Det er i beste fall naivt å tro at et eget EUbyrå, som ikke bryr seg om annet enn EUrettens minimumsbestemmelser, skal
bli et bolverk mot sosial dumping, hevder Kleveland overfor FriFagbevegelse.no.
Støttespillere
I et blogginnlegg skriver Robert R. Hansen, LOs seksjonsleder for Europa, at han ønsker forslaget om et arbeidsmarkedsbyrå innen EU velkommen.
Han mener det vil styrke trepartssamarbeidet, og at innføringen av et slikt byrå vil styrke arbeidslivspartenes innflytelse på det arbeidet som gjøres i arbeidet mot sosial dumping og arbeidslivskriminalitet.
Også lederen av Europabevegelsen, Heidi Nordby Lunde, er begeistret over at EU tar tak i problematikken innen arbeidslivsområdet i Europa. Hun mener forslaget om å opprette et arbeidsmarkedsbyrå innen Europa er et viktig skritt i retning av et mer sosialt Europa. – Fri flyt av varer, handel og tjenester har vært positivt, men vi må erkjenne at det ikke har vært godt nok regulert og har bidratt til utfordringer mellom land. Nå tar EU grep for å løse de problemene, sier Nordby Lunde.
Ferie er for de fleste sol, sommer og tid sammen med familie og venner. Valg av tid for avvikling av ferie kan av og til skape noen problemer på arbeidsplassen. Vet du hvilke regler som gjelder dersom du blir syk i ferien, eller hvor mange feriedager du har rett til?
Av: Lene Liknes Hansen og Eva Borhaug
I et harmonisk arbeidsforhold vil partene som regel bli enige om når ferien skal tas ut og hvor lang ferie man tar om gangen. Det vil også være naturlig for arbeidsgiver å forhøre seg med arbeidstaker når man ønsker å ta ut ferie.
Hvor mange feriedager har du krav på?
Ferieloven legger opp til at arbeidsgiver skal drøfte feriefastsettingen med den enkelte arbeidstaker eller med de tillitsvalgte. Arbeidstaker kan kreve å få underretning om feriefastsettingen tidligst mulig og senest to måneder før ferien starter, såfremt ikke særlige grunner er til hinder for dette. Både underretning senest to måneder før og drøftingsplikten er såkalte ordensregler, noe som betyr at det ikke får noen konsekvenser dersom arbeidsgiver unnlater å følge disse reglene.
Alle, uansett stillingsprosent, har rett på fire uker og én dag ferie (25 virkedager –ferieloven opererer med lørdag som virkedag). I tillegg har de fleste som er omfattet av en tariffavtale rett på fem ukers ferie (30 virkedager). Ved bytte av jobb eller tiltredelse i ny jobb, har man som hovedregel rett til full ferie dersom man starter å jobbe i den nye stillingen senest 30. september i ferieåret. Arbeidstakere som tiltrer etter denne datoen har kun rett på ferie i seks virkedager. Begge tilfeller forutsetter imidlertid at det kan godtgjøres at full ferie ikke allerede er avviklet hos annen arbeidsgiver tidligere samme år.

Fyller du 60 år i løpet av ferieåret, har du rett på seks virkedager ekstra ferie. Denne ekstraferien kan tas ut akkurat som det passer deg, enten samlet eller med en eller flere dager om gangen. Deles ekstraferien, kan du imidlertid bare kreve å få fri så mange arbeidsdager som du normalt har i løpet av en uke. Du skal gi arbeidsgiver minst to ukers varsel før avvikling av denne ekstraferien.
Vær oppmerksom på at fridager i turnusarbeid eller deltidsarbeid også regnes som feriedager i ferieperioden. Disse dagene går altså til fradrag i ferietiden.
Er du usikker på hvor lang ferie du har rett på, kan du sjekke med HRavdelingen eller personalansvarlig.
Når skal ferien tas ut?
Det er mest vanlig å ta ut størsteparten av ferien i skoleferien. Hovedferieperioden etter ferieloven regnes fra 1. juni til 30. september. I denne perioden har arbeidstaker rett på tre uker sammenhengende ferie. Det er likevel arbeidsgiver som til syvende og sist bestemmer når ferien skal tas ut dersom partene ikke blir enige. Restferien kan også kreves tatt i sammenhengende arbeidsdager. Arbeidsgiver kan altså få problemer med å dele opp denne ved for eksempel å si at arbeidstaker må ta ut tre feriedager i påskeuken og to dager i romjulen. Har man den femte ferieuken vil dette bli enklere for arbeidsgiver. Her kan arbeidsgiver kreve at arbeidstaker tar
ut restferien samlet i påskeuken og deretter den avtalefestede ferien samlet i for eksempel romjulen.
Dersom ferien er fastsatt og du som arbeidstaker har mottatt informasjon om dette, kan arbeidsgiver som hovedregel kun endre tiden for ferie dersom dette er nødvendig på grunn av uforutsette hendelser som vil skape vesentlige driftsproblemer og det ikke kan skaffes stedfortreder. Endringer skal drøftes, og arbeidstaker kan kreve erstatning for dokumenterte merutgifter dersom avtalt ferie endres. Arbeidstaker plikter i så tilfelle å gi opplysninger om merutgiftene i drøftingene. Dersom man ikke gjør det, får man kun dekket merutgifter i den utstrekning de fremstår som nærliggende følger av omleggingen.
Disse reglene om endring av ferie gjelder likevel ikke dersom ferien endres som følge av ferieavvikling i oppsigelsestid eller ferieavvikling ved sykdom, permisjon, arbeidskamp eller lignende.
Ferieavvikling i oppsigelsestid
Dersom du har sagt opp stillingen din, kan du be om uttak av ferie i oppsigelsestiden. Dette krever enighet fra arbeidsgiver. Arbeidstaker kan kreve tre uker i sammenheng dersom oppsigelsestiden er i hovedferieperioden. Tiden for fastsatt ferie kan ikke uten arbeidstakers samtykke endres på grunn av oppsigelse, med mindre det er nødvendig på grunn

av uforutsette hendelser og dette vil skape vesentlige driftsproblemer der det ikke kan skaffes stedfortreder.
I situasjoner hvor arbeidsgiver har gått til oppsigelse av arbeidstaker, kan arbeidsgiver kreve at arbeidstager tar ut ferie i oppsigelsestiden, men kun dersom oppsigelsesfristen er tre måneder eller lengre. Ved kortere oppsigelsesfrist må arbeidstaker samtykke i at ferien blir lagt i oppsigelsestiden. Dersom arbeidstaker og arbeidsgiver allerede før oppsigelsen har avtalt ferie som faller i oppsigelsestiden, kan arbeidstaker likevel motsette seg avvikling av ferie i denne perioden.
Arbeidstaker kan uansett kreve at ferie avvikles før oppsigelsesfristens utløp, hvis det etter dette tidspunktet ikke er tid til å avvikle ferie innenfor hovedferieperioden eller ferieåret. Arbeidstaker som selv sier opp sin stilling etter 15. august, kan likevel ikke kreve at ferie legges til tiden før 30. september.
Hva om du blir syk i ferien?
Det hender at man blir syk i ferien. Hvordan skal man da forholde seg? Man må her skille mellom sykdom som oppstår før avtalt ferie starter og sykdom som oppstår i selve ferien.
Dersom arbeidstaker blir syk før ferien starter, kan man kreve at ferien utsettes til senere i ferieåret. Kravet må dokumenteres med legeerklæring og fremsettes senest siste arbeidsdag før ferien starter.
Blir man syk mens man har ferie, kan man kreve at et tilsvarende antall virkedager ferie utsettes og gis som ny ferie senere i ferieåret. Igjen må kravet dokumenteres med legeerklæring og må fremsettes uten ugrunnet opphold etter at arbeidet er gjenopptatt. Er man fortsatt syk etter at ferien er avsluttet, bør man så snart som mulig melde fra til arbeidsgiver om at man krever ferien utsatt. Dette kan for eksempel gjøres samtidig som man sender inn

sykemelding. Går det for lang tid, risikerer du å tape kravet om utsatt ferie.
Ferieavvikling under foreldrepermisjon
Arbeidsgiver kan ikke, uten arbeidstakers samtykke, legge ferie til permisjonstid hvor det ytes foreldrepenger etter folketrygdloven. Dette gjelder imidlertid ikke hvis man kun har gradert permisjon. Tilsvarende krav til samtykke ved ferie i permisjonstiden gjelder for fedre og andre omsorgspersoner som har permisjon i tilknytning til fødsel etter arbeidsmiljølovens bestemmelser om omsorgspermisjon.
Arbeidstaker kan likevel kreve å avvikle lovbestemt ferie i løpet av permisjonstid hvor det ytes foreldrepenger, slik det er beskrevet i folketrygdloven paragraf 149 om full foreldrepermisjon og paragraf 1416 om gradert foreldrepermisjon.
Faller permisjonstid sammen med allerede fastsatt ferie, kan arbeidstaker kreve utsettelse av de feriedagene som omfattes av permisjonstiden.
Overføring av ferie
Ifølge ferieloven kan man avtale med arbeidsgiver å overføre inntil tolv
virkedager av den lovfestede ferien til neste ferieår. Det samme gjelder den avtalefestede ferien. Dette innebærer altså at man kan avtale å overføre inntil 17 virkedager (14 arbeidsdager) totalt til neste ferieår, noe som må avtales skriftlig med arbeidsgiver.
Ferie som i strid med lovens bestemmelser eller på grunn av sykdom eller foreldrepermisjon ikke er avviklet ved ferieårets utløp, skal overføres til neste ferieår. Hvis arbeidsgiver er skyld i manglende ferieavvikling, kan arbeidstaker kreve erstatning. Husk at arbeidsgiver plikter å sørge for at arbeidstaker tar ut minst 25 virkedager i ferie hvert år, og at arbeidstaker har tilsvarende plikt til å avvikle disse feriedagene.
Rett til forskuddsferie
Man har rett til skriftlig å avtale forskuddsvis avvikling av ferie i inntil tolv dager.
Feriepenger
Feriepenger fra arbeidsgiver beregnes på grunnlag av lønn som er utbetalt i opptjeningsåret. Ved vanlig ferieavvikling får man utbetalt feriepenger av lønn opptjent året før. Dersom arbeidsforholdet avslut
• Unngå å ta med mye kontanter og svært kostbare gjenstander. Benytt helst kredittkort.
• Kontroller utløpsdatoen på kortet.
• Fordel kontanter og kort på flere steder, ikke ha alt i samme lomme eller veske. Ha heller ikke med deg for mye av verdi på stranden og lignende.
• Ha aktuelle varslingsnummer lett tilgjengelig i tilfelle sykdom, ulykke eller tyveri.
• Kontakt politi hvis du blir utsatt for tyveri. Få alltid en kopi av anmeldelsen.
• Kontakt nærmeste konsulat og reiseleder dersom du blir ranet og ikke har penger.
• Legg ikke verdigjenstander synlig i bilens kupé på bilferie.
Kilde: Finans Norge
tes, vil man ha krav på å få feriepenger utbetalt også for året man blir oppsagt, uavhengig av om det er tatt ut ferie det året.
Den vanlige prosentsatsen er 10,2 prosent av feriepengegrunnlaget. Arbeidstakere som omfattes av en tariffavtalt femte ferieuke har en prosentsats på tolv prosent. For arbeidstakere over 60 år med rett til ekstraferie forhøyes prosentsatsen ytterligere med 2,3 prosent.
Forholdet mellom ferie og feriepenger
En vanlig ordning er at arbeidsgiver utbetaler feriepenger i juli i stedet for lønn. Det er da viktig å være klar over at det ikke er noen direkte sammenheng mellom ferie og feriepenger. Ferie er rett og slett krav på fri uten lønn for en nærmere bestemt periode. Feriepenger er derimot krav på en tilleggsutbetaling for opptjent lønn.
Arbeidstaker kan kreve å få feriefritid uavhengig av opptjeningen av feriepenger. Tilsvarende kan arbeidstaker motsette seg avvikling av ferie i den utstrekning feriepengene ikke dekker lønnsbortfallet under feriefraværet.
• Ved reiser til områder med dårlige hygieniske forhold er det økt risiko for infeksjoner som smitter gjennom mat og vann. Symptomer er vanligvis diaré og oppkast. Smittestoffene drepes ved koking og steking.
• Vær forsiktig med kalde sauser, upasteuriserte melkeprodukter, ikkemeieripakket iskrem, mat tilberedt av rå egg (majones, desserter), salat, rå skalldyr og halvstekt eller rått kjøtt.
• Du kan trygt spise nylaget kokt eller stekt mat som fortsatt er varm, likeså frukt og grønnsaker som du selv skreller. Vær nøye med å vaske hender etter toalettbesøk, etter kontakt med dyr og før matlaging og måltider.
• Du kan drikke nykokt, varm te og kaffe og (mineral)vann fra flasker du selv åpner. Det frarådes vanligvis å drikke vann fra springen. Isbiter av forurenset vann er en velkjent smittekilde. Kilde: Folkehelseinstituttet

• Barn
Små barns hud er spesielt sårbar for sterk sol. Spedbarn bør unngå soling. Småbarn bør ha klær som dekker større deler av kroppen, eller holdes i skyggen.
Barn er også spesielt sårbare for sykdommer, særlig diaré. Før turer til Sør og ØstEuropa og tropiske/subtropiske strøk bør barn være fullvaksinert for sin alder med de vaksinene som inngår i barnevaksinasjonsprogrammet. For spedbarn kan vaksinasjonsprogrammet eventuelt fremskyndes. Spør på helsestasjonen i god tid før avreise.
• Gravide
Gravide utsetter seg for en viss risiko ved å reise utenlands, særlig til tropiske strøk og ved reiser under primitive forhold. Spør på svangerskapskontrollen.
• Kronisk sykdom eller funksjonshemming
Personer med kronisk sykdom eller funksjonshemming bør rådføre seg med legen sin før reisen. Det samme gjelder hivpositive personer med nedsatt immunforsvar eller andre med svekket immunforsvar, som lettere kan utvikle sykdom under utenlandsreise.
• Innvandrere
Etter noen år i Norge har innvandrere vanligvis ingen beskyttelse mot de hyppigst forekommende, smittsomme sykdommene i sitt opprinnelige hjemland. Det er derfor viktig at også innvandrere blir beskyttet med vaksinasjon og bruker forebyggende tiltak mot malaria også før de besøker tidligere hjemland.
• Vaksiner/forebyggende legemidler Informasjon om forebyggende tiltak fås hos kommunehelsetjenesten/fastlegen. Det gjelder også for vaksiner og nødvendige resepter. Ta kontakt i god tid. I noen tilfeller må vaksinasjonen begynne flere uker før avreise.
Kilde: Folkehelseinstituttet

Mye prisjuks avsløres av et europeisk tilsyn med reiselivsformidlere. Forbrukerombud Elisabeth Lier Haugseth sier best pris ikke alltid er best.
Rapporten viser at i en tredel av tilfellene var prisen som kunden først fikk se, ikke den endelige prislappen, og ett av fem markedsførte tilbud var likevel ikke tilgjengelig. Kunder blir også lurt til å tro at det bare er få ledige rom igjen på overnattingsstedet, mens det i virkeligheten er flere – bare at disse er tilgjengelige på andre nettsider.
– Man kan ikke gi inntrykk av at hotellovernattingen koster mindre enn den faktisk gjør. Den markedsførte prisen skal være totalprisen. Den skal inkludere alle utgifter du må betale, sier Lier Haugseth.
Ikke superbillig
Når det gjelder fly, legges billetter ofte ut superbillig på nettet.
– Men så ser vi at det påløper nye kostnader, som seteavgift, bagasjeavgift etc. Når du har kommet deg gjennom bestillingen, så ser du at du har fått en helt annen pris, men så orker du ikke å begynne på nytt, sier Lier Haugseth.
Hun sier også at sammenligningssider kan være forvirrende, fordi de ikke gjenspeiler alle tilleggsutgifter som plutselig kan renne på. Hun er også opptatt av at folk kan bli lurt av brukeromtaler av hoteller.
– Man må være klar over at brukeromtaler ikke gir det fulle og hele bildet av et hotell eller en leverandør. Ikke alle negativer omtaler kommer fram, eller omtaler kan være redigert. Vi har gjennom tilsynet sett at brukeromtalene ofte fremstår bedre enn de egentlig er, sier hun.
Forbrukere må sjekke informasjonen bedre, er budskapet. @ NTB
Gutta sa hun var for liten, skolens rådgiver at det ville bli for vanskelig. Det ga
Parat-medlem Janne Handrum (20) blaffen i. Nå lærer hun å mekke F-16, men drømmer allerede om å stramme grepet om mutterne på F-35.
En ung mann passerer. Hilser kjekt med hånda til panna, på militært vis. Seks–syv demonterte jetmotorer står langs en vegg. Et langt, sort forheng skjuler noe som er hemmelig.
Lærling på F-16 og Sea King Janne går i læra som flysystemmekaniker hos AIM Norway på Kjeller. Nå viser hun
AIM Norge har elleve lærlinger. Fem av dem er jenter. Men noen kvotering vil avdelingssjef Søisdal ikke gå med på. – Hos oss har det ingenting å si om du er jente eller gutt. Det som er viktig, er hva du yter. Om du har interesse og vil, sier han.
Søisdal sier AIM plukker de beste når de skal ta inn lærlinger.

– De må både ha gode karakterer og egne seg. Vi ser etter den spesielle typen; ungdommen som har interesse for faget, som graver seg litt ned, er nøyaktig og kan forholde seg til regler og rammer, sier han.
Tiden hos AIM Norge gir Janne og de andre lærlingene et gullkantet utgangspunkt. De kommer til å kunne velge og vrake i jobber. For som ferdig utdannet flymekaniker fra hangaren her på Kjeller kan Janne mekke på hva hun vil: Fly eller helikopter. Militært eller sivilt. Tog eller
Drømmer om Amerika
– Hva jeg driver med nå? Jeg tar ut en vingebolt. Det skal være inspeksjon i spantet der bolten sitter, sier Janne.
Halvparten av lærlingene hans er jenter, men
Anders Søisdal, sjef for Flyavdelingen hos AIM Norway på Kjeller, avviser alle tanker om kjønnskvotering.
– Nei, det driver vi ikke med. Her er det kun egnethet som teller, sier han.
Janne Handrum går i læra som flysystemmekaniker hos
AIM Norway. Her lærer hun blant annet å reparere og vedlikeholde norske jagerfly.
Handrum går i lære som flysystemmekaniker hos
AIM Norway. Interesserer: bilsport, dans og reiser. Liker å skru på motorer. Fikk sin første motorsykkel som femåring. Følg
Janne på Snapchat (Janne98) eller Instagram (ambassadorhandrum).


Myndighetene ønsker å øke unges interesse for yrkesfaglige utdanningsvalg, antall lærebedrifter og læreplasser. Worldskills Norway (WSN) er ansvarlig for kampanjen. Få informasjon på yrkesfag.no, enten du er elev, lærer, forelder eller representerer en bedrift:
#yrkesfag, #yrkesfagenesår eller #mittyrkesfag.

Med fagbrev som flysystemmekaniker kan Janne Handrum velge og vrake i jobber. Hun vil være kvalifisert som mekaniker for fly, helikopter, tog eller båt.
Hva som er drømmen min? Målet akkurat nå er å ta fagbrevet, men jeg kunne godt tenke meg å sitte i USA og skru på F-35, sier Janne.
Bedriften reparerer og vedlikeholder fly og helikoptre og holder til ved Kjeller flystasjon utenfor Lillestrøm. Forsvaret er hovedkunde. De største oppdragene er vedlikehold og modifikasjoner av F-16 og Sea King. AIM Norway har ca. 470 ansatte.
Hun synes dette er artig. – Har vært i Bodø og demontert en del vinger. Det blir enda mer moro når du har gjort en jobb ofte. Da kan du være mer selvstendig, sier hun.
– «Janne!» hoier en kar i arbeid på en annen F 16maskin. – Får jeg låne den halttomovergangen av deg ganske kjapt?
– «Ja!» roper Janne tilbake.
Hun spretter lettbeint over skroget på kampflyet og ned på betongen.
– Vi driver med tungt vedlikehold på flyene, sier ungjenta, tilbake på stillaset som omslutter den smekre flykroppen.
Hun forklarer at de går inn i systemet, inspiserer og reparerer.
– Ellers er strukturen i skroget eget fagområde på F16, sier hun.
Uka etter ventes tre flunkende nye F35, rapporterer Forsvarsdepartementet. De flys over fra fabrikkanlegget i Texas og lander på Ørland flystasjon utenfor Trondheim. Da vil Forsvaret ha seks av de nye F35 stasjonert på norsk jord. I tillegg står syv slike kampfly på en amerikansk treningsbase.
I løpet av de to neste årene vil trening av piloter og vedlikeholdspersonell bli svært viktig. De nye flyene vil først være fullt ut operative i 2025.
– Hva som er drømmen min? Målet akkurat nå er å ta fagbrevet, men jeg kunne godt tenke meg å sitte i USA og skru på F35, sier Janne.
Framtida er åpen. – Jeg flytter dit det er nødvendig. Jeg blir neppe arbeidsledig, sier hun.
Ambassadør for #yrkesfag 2018 er blinket ut som «Yrkesfagenes år». Målet er å få flere ungdommer til å velge yrkesfag. Arbeidslivet trenger dem.
I likhet med de andre lærlingene hos AIM Norway er Janne medlem av Parat. Slik ble det til at hun sa ja til å stille opp som ambassadør for kampanjen. Gjennom året skal hun fortelle andre ungdommer hvordan det er å utdanne seg til et yrkesfag.
For Jannes egen del var det ikke opplagt at hun skulle til Kjeller og mekke jagerfly. Det var mange som «ikke hadde trua», som hun selv uttrykker det.
– Pappa, som er bilmekaniker, ble med meg på masse yrkesmesser. Sammen så vi på de forskjellige løpene du kunne gå. Pappa har vært positiv hele veien. Mamma, som er regnskapsfører, sa: «Gjør det du har lyst til å gjøre.»
Valget falt på elektro. – Da fikk jeg høre av gutta at det kunne jeg ikke, fordi jeg var jente. Og så var jeg jo så lita. Men jeg tenkte at jeg skal vise dem at det går an.
Elevene skulle velge retning videre, og flyfaget kom opp som en av flere muligheter. – Igjen fikk jeg høre at jeg ikke kunne. Rådgiveren mente det ville bli for vanskelig å komme inn. At det ikke var noen vits i å prøve. Igjen ble jeg irritert på at folk ikke hadde trua.

Handrum er YS-ambassadør under «Yrkesfagenes år 2018». Ved å fortelle om egen læretid skal hun motivere flere ungdommer til å velge yrkesfag. – Lytt til deg selv og dine egne ønsker. Ikke foreldre eller venner, er Jannes klare råd.
Janne søkte. Fikk plass og hadde det som plommen i egget.
– Jeg følte meg veldig velkommen på flyfaget og stortrivdes. Nå kan jo de som ikke hadde trua se at jeg har fått det til. Selv om jeg er jente og lita, sier Janne.
Berg-og-dal-bane-junkie
Norge har i alt 57 F16 per dags dato, men som skal erstattes av F35 etter hvert. Hva som da skjer med basen på Kjeller, er usikkert, for øvrig en av verdenes eldste baser i operasjon.
Ifølge Anders Søisdal er det mulig AIM Norway flytter basen til den militære flyplassen på Rygge i Østfold.
– Det er ikke avgjort, men det som er sikkert, er at vi kommer til å jobbe med fly i en eller annen form, sier Søisdal.
Dagen før Paratbladets besøk var forsvarsminister Frank BakkeJensen på AIM. – Når forsvarsministeren kommer på besøk, gjelder det å ha noe å gjøre, å se litt opptatt ut. For da slipper du å bli spurt om ting, smiler Janne lurt.
En prøvetur med ett av flyene hun jobber med synes hun derimot ikke virker det minste skummelt.
– Jo, jeg kunne godt tenke meg å få sitte på med et F16 en gang. Det hadde vært kjempegøy. Jeg har sittet på med helikop
ter. Jeg er en bergogdalbanejunkie, sier hun.
Søisdal sier han har jobbet her i snart 28 år, men ikke fått fly med et F16 ennå, antagelig for å skru ned eventuelle forhåpninger om det umulige.
Men det er ikke godt å vite hva det er mulig å få til når det gjelder Janne. Hun har nemlig trua.

Parat-leder Hans-Erik Skjæggerud er leder for YS-komiteen som deler ut likestillingsprisen 2018.
Likestillingsprisen blir delt ut på YSkonferansen 30. Oktober, og vi trenger din hjelp til å finne den beste kandidaten. Formålet med prisen er å stimulere til økt innsats i arbeidet for å fremme likestilling og like muligheter for alle. Med likestilling mener vi alle tiltak som virker til å rette opp skjevheter når det gjelder muligheter til samfunnsdeltakelse, utdanning, arbeid og faglig utvikling.
Prisen kan gis til enkeltpersoner, grupper, organisasjoner samt private eller offentlige virksomheter, og både innen og utenlands. Godt begrunnede forslag kan sendes inn på www.likestillingsprisen.no eller www.ys.no innen 15. august.
Parat har fått nye websider. Den nye siden skal gjøre det enklere å finne det du er på jakt etter. Det første som møter deg, er spørsmål om hva vi kan hjelpe deg med. Den nye siden bruker Google som søkemotor, men søket er avgrenset til innhold på Parats sider.
Den nye hjemmesiden skal være like bra på mobil og nettbrett som på PC og Mac.
Parat.com har ikke lenger nyheter. Nyhetene er samlet på parat24.com. Parat24 er underlagt Redaktørplakaten og Vær varsomplakaten. Har du tips til forbedringer, kan du sende dem til webmaster@parat.com

Nye nettsider for web og mobil på www.parat.com.

Parats leder HansErik Skjæggerud gir honnør til Equinor (tidligere Statoil) for innføringen av en global ordning med 16 ukers foreldrepermisjon. – Equinor har med dette iverksatt et bra tiltak for den enkelte ansatte rundt om i verden som ikke har slike rettigheter gjennom nasjonale velferdsordninger. Det er også et viktig signal til omverdenen om hva vi i Norge mener må til for å bedre likestilling mellom kjønnene, sier Skjæggerud.
Parats hovedstyre har oppnevnt Reidun Nordgulen fra region vest som ny representant i det sentrale pensjonistutvalget i Parat. Utvalget består nå av Tore Grini (leder), John Giæver og Reidun Nordgulen.
Parat Pensjonist skal gi tilbud om sosiale, kulturelle og faglige aktiviteter for pensjonistmedlemmer i Parat. Det er aktive pensjonistgrupper i Oslo/Akershus, Hordaland og i Trøndelag. I tillegg er det kontaktpersoner i Vestfold, Telemark og Nordland.
For å opprettholde medlemsfordelene i Parat etter yrkeslivet er det en fordel å være medlem for blant annet å beholde gode forsikringsordninger. Husk å melde fra til medlem@parat.com når du går av med pensjon.

Leder for Parat Pensjonist Tore Grini. Foto: Parat.
AnnBritt S. Gjølstad fra Finn.no ble årets tillitsvalgt i Parat Media. Hun er tillitsvalgt i Finn.no, og prisen ble delt ut av Parat Medias leder på årets representantskapsmøte som ble avholdt i Nice i Frankrike.

Leder i Parat Media Liz Ovesen beskriver årets tillitsvalgt som en dame som kjennetegnes ved sin standhaftighet og ved sin løsningsorienterte tilnærming til problemer som dukker opp.
RU region Nord (Finnmark, Troms, Nordland):
Leder: Lars Raymond Holm, Luftfartstilsynet
Epost: Lrh@caa.no
Johanne Hagerupsen, Høgskolen i Harstad
Epost: johanne.hagerupsen@hih.no
AnneKatrine Thomassen, Brønnøysundregisterne
Epost: akt@brreg.no
TorFredrik Olsen, Finnmark Fylkeskommune
Epost: tor.fredrik.olsen@ffk.no
Åse Helen Andersen, Apotek 1 Hammerfest
Epost: aasehelande@hotmail.com
Terje Grytdal Roland, NordTroms Tingrett, UNGrepresentant
Epost: terje.grytdal.roland@domstol.no
RU region Midt (Trøndelag, Møre og Romsdal):
Leder, Jannike Hanssen, Statens vegvesen
Epost: Jannike.hanssen@vegvesen.no
Morten Mørch, NTNU
Epost: Morten.morch@ntnu.no
Siri Finseth, Namsos kommune
Epost: SiriStinessen.Finseth@namsos.kommune.no
Grete Kambuås, Boots Apotek
Epost: gretkam@online.no
Marit Holstad Aarsæther, Høgskolen i Volda Epost: maritaa@hivolda.no
Mona Nerland, Politiet i Molde, UNGrepresentant
Epost: mona.nerland@politiet.no
RU region Øst (Østfold, Hedmark, Oppland, Oslo og Akershus):
Leder: Hilde Margrete Bjørklund Cappelen Damm AS Epost: hilde.bjorklund@cappelendamm.no
Bente Iren Tollefsen Moen Statens Pensjonskasse
Epost: bente.iren.moen@spk.no
Stein Grindheim SAS Ground Handling Epost: stein.grindheim@sas.no
Leder i Parat UNG, Idar Gundersen, er YS’ deltaker på Genèveskolen. Formålet med skolen er å øke felleskapets forståelse av det nordiske samarbeidet og øke bevisstheten om globalisering og internasjonalisering, i tillegg til økt kjennskap til ILO og andre internasjonale organisasjoner.

Genèveskolen foregår samtidig som ILOkonferansen (mai/juni), og deltakerne på skolen følger konferansen tett. I år jobber ILOkonferansen blant annet med å få på plass en konvensjon om vold og trakassering i arbeidslivet.
Ronny Kjønsø Asko Øst Epost: ronny.kjonso@asko.no
Anja P. Ahlstrøm – NIBIO Epost: Anja.Ahlstrom@nibio.no
Hans Andreas Bøhmer, Securitas i Oslo, UNGrepresentant
Epost: hanboh@gmail.com
RU region vest (Rogaland, Hordaland, Sogn og Fjordane):
Leder: Rune Skaar, Bergen kommune
Epost: rune.skaar@bergen.kommune.no
Vidar Alfei, NAV Økonomitjeneste Epost: vidar.alfei@nav.no
Hege Solbakken Sæbø, Stavanger Aftenblad AS Epost: hege.solbakken.saebo@aftenbladet.no
Wibecke Søraas Onarheim, Gulating lagmannsrett Epost: wibecke.soraas.onarheim@domstol.no
Gro Nondal Buvik, Sognekraft AS Epost: gro.nondal.buvik@sognekraft.no
Erik Andreassen, Gate gourmet i Bergen, UNGrepresentant
Epost: eandreassen@gategourmet.com
RU region Sør (Aust og Vest Agder, Telemark, Vestfold og Buskerud):
Leder: Ragnhild Negård – NAV
Epost: ragnhild.negard@nav.no
Nina Ødegård – Høyskolen i Buskerud og Vestfold
Epost: Nina.Odegard@hbv.no
Cecilie Holt, NAV
Epost: cecilie.holt@nav.no
JohnInge Nerland – Fylkesmannen i Buskerud
Epost: fmbujin@fylkesmannen.no
Anne Britt Skomedal, Vitusapotek Elefanten Kristiansand Epost: annebritt1962@hotmail.com
Lahvry Helene Fürst Bright, UNGrepresentant
Epost: lahvry@hotmail.com
Vi som gir svar i denne utgaven av Parat er:






Har du spørsmål til juristene eller til forhandlingsavdelingen, kan du sende spørsmålene til trygve.bergsland@parat.com. Vi hjelper deg som medlem med alle typer problemstillinger knyttet til arbeidsforhold og tolkning av avtaleverket. Du kan også ta kontakt med oss når det er behov for skriftlig og muntlig rådgivning i forbindelse med omorganisering, nedbemanningsprosesser, ferie, arbeidstidsordninger, trygdespørsmål og lignende.
Antall feriedager
Vi har rett til fem ukers ferie på jobben og har fått beskjed av arbeidsgiver at vi kan dele en ferieuke, og ta enkeltdager ferie. Jeg jobber 80 prosent stilling og har fri hver fredag. En vanlig arbeidsuke er jo fem dager, men arbeidsgiver sier jeg bare får fire enkeltdager ferie. Er dette riktig?
Amelia
Svar: Det er riktig at stillingsprosent og arbeidstidsordning har betydning for hvor mange feriedager du kan ta når ferien deles. Ferie etter ferieloven, som er fire uker og én dag, har ingen bestemmelse som gir klar rett til å dele ferien. Lovens system bygger på at ferie skal tas i hele uker. Men det er selvsagt mulig å avtale at også denne ferien deles. I tillegg har dere tariffavtale på arbeidsplassen, noe som gir rett til ytterligere fire
dager ferie (ved femdagers uke). Denne ferien har dere en avtalefestet rett til å dele. Bestemmelsen sier at «deles den avtalefestede ferien, kan arbeidstaker bare kreve å få fri så mange dager som vedkommende normalt skal arbeide i løpet av en uke». Så hvis du jobber 80 prosent, og har fire dagers uke, vil du ha rett til fire enkeltdager ferie.
Grete
Går arbeidsavtalen foran tariffavtalen?
I arbeidsavtalen min står det at jeg har rett på ekstra godtgjørelse for å komme på jobb fordi jeg har lang reisevei. Men nå har min fagforening gått med på et ønske fra arbeidsgiver om å spare penger, og ifølge tariffavtalen har ingen ansatte rett på godtgjørelse for oppmøte på jobb uansett reisetid og lengde. Arbeidsgiver mener det innebærer at jeg mister min individuelt avtalte rett på denne ekstra godtgjørelsen som årlig sikrer meg 10 000 kroner. Det kan da ikke være riktig?
William
Svar: Jo, det er slik at den kollektive avtalen din fagforening har inngått på vegne av fellesskapet, går foran den individuelle. Det følger direkte av arbeidstvistloven paragraf 6: Bestemmelse i arbeidsavtale som strider mot en tariffavtale som begge parter er bundet av, er ugyldig.
Denne bestemmelsen beskyttes tariffavtalens verdi som normgivende. Da kan den ikke uthules eller settes til side av arbeidsgiver ved å inngå individuelle avtaler som undergraver avtalen. Samtidig innebærer dette at de tillitsvalgte har mye makt og ansvar når de forhandler på medlemmenes vegne. Det er på den måten fagforeningenes mulighet til å påvirke lønns- og arbeidsvilkårene sikres for alle. Det er bare dersom det er direkte motstrid mellom din individuelle avtale og tariffavtalen, at den individuelle avtalen må vike. Som oftest vil det ikke være motstrid, og da utfyller de to avtalene hverandre.
Christen
Foreldrepermisjon
Jeg jobber på et sykehus i Oslo, og til sommeren venter jeg og min kone vårt første barn. I den forbindelse lurer jeg på om det stemmer at jeg i tillegg til avtalt foreldrepermisjon har rett til to uker permisjon med lønn i forbindelse med fødselen?
Martin
Svar: Ja, det stemmer. I henhold til gjeldende avtale skal arbeidstaker som tar omsorgspermisjon etter bestemmelsene i arbeidsmiljølovens være sikret fri med full lønn i to uker (ti dager). Permisjon etter denne bestemmelse skal normalt avvikles i løpet av de første to ukene etter hjemkomst.
Renate
AFP – tariffavtale og rettigheter for enkeltpersoner
Jeg har nylig meldt meg inn hos dere. Grunnen til innmeldingen er at jeg har lest om fordelene med avtalefestet pensjon (AFP). Vi er 200 ansatte, og det er ingen som har AFP i dag. Hva skal til for at jeg kan omfattes av en AFPordning, og trenger dere ytterligere informasjon fra meg for å få dette på plass?
Thea
Svar: For å kunne få opprettet en AFPordning i en bedrift i privat sektor, så må det først opprettes en tariffavtale i virksomheten. AFP er ingen individuell rettighet, det er en kollektiv rettighet – som gir enkeltpersoner rettigheter når tariffavtale er på plass og øvrige vilkår er til stede.
For at Parat skal kunne opprette en tariffavtale, må vi først ha et tilstrekkelig medlemsgrunnlag i bedriften for å få opprettet en tariffavtale. Er arbeidsgiver medlem av en arbeidsgiverforening, kreves det at ti prosent av de aktuelle er medlem av Parat. Dersom bedriften ikke er organisert, bør vi som hovedregel ha om lag 50 prosent av de ansatte som medlemmer i Parat. Når tariffavtale er opprettet, meldes virksomheten inn i AFP-ordningen. Bedriften må betale premie inn til ordningen, og alle ansatte i en virksomhet er dermed omfattet av ordningen. For at den enkelte skal kunne benytte seg av ordningen, så må de individuelle vilkårene være oppfylt, se eventuelt afp.no for mer informasjon.
Kjell Morten
Ferie og sykdom
Jeg tok ut en ferieuke tidligere i måneden. Dessverre ble datteren min syk samme uke, og jeg brukte to av dagene til å passe på henne. Kan jeg få disse fridagene tilbake, og kan jeg bruke dem senere? Hadde jeg ikke hatt ferie, ville jeg jo uansett måttet være borte fra jobb.
Yngvil
Svar: Ferieloven inneholder regler om at en arbeidstaker som har vært syk i ferien, kan kreve ferien utsatt, og at sykedagene gis som ny ferie senere. Rettighetene i ferieloven gjelder arbeidstakers egen sykdom. Det er dessverre slik at dersom det ikke er du selv som er syk, men bruker ferien til å pleie sykt barn, gir ikke dette rett til ny ferie.
Maren
Promilleregler i båt
Jeg liker å være på Oslofjorden med snekka mi, og jeg liker å ta noen pils. Jeg kan ikke kjøre bil etter en slik tur, men jeg er usikker på om jeg kan bli promilledømt på fjorden. Snekka går sakte, og jeg har god styring hele veien.
Johannes
Svar: På sjøen kan du ha maksimalt 0,8 promille for å føre en båt. Dette gjelder småbåter som har motor som framkomstmiddel. Du bør derfor ikke drikke alkohol når du er på tur med snekka. Blir du kontrollert av politiet, blir du straffedømt. Om du har årer i båten, kan du kanskje komme unna, men i småbåtloven er det et krav om at du må være skikket om du skal føre en båt, også en robåt. Det beste vil derfor være å unngå alkohol når du skal føre en båt.
Thore

Løsningen på kryssordet i medlemsbladet Parat nummer. 1 – 2018 er: «BLIKKSTILLE IDYLL»
Den heldige vinneren er: Hege Dahl Moen, fra Trondheim. Frist for å sende inn løsning på neste kryssord er: 3. september 2018.
Vi trekker én vinner hver gang. Send løsningen til redaksjonen, enten som e-post til trygve.bergsland@parat.com eller ordinær post til: Parat, Postboks 9029, Grønland, 0133 Oslo
Løsning:
Husk å merke e-posten/konvolutten «Kryssord 2/2018» Husk også å skrive på ditt eget navn og adresse.
Premie: Elvang Latitude alpakka-pledd av 50 prosent alpakkaull, 40 prosent fåreull og 10 prosent mikrofiber. Pleddet er Fair Trade-sertifisert. Målene er 130x200 centimeter (se foto).

Vannrett
1. Liggeunderlag
6. Urørlig
7. Fikk øye på
10. Søtsaker
11. Krydderblanding
12. Engelsk bestemt form 14. Ledd
16. Ledelse 17. Loslitt 19. Fangstredskap
1.
2.
3.
4. Kappe
5. Lealaus 8. På grunn av 9. Øst-Tyskland 11. Babbel
13. Glød 15. Kolle
18. Oss to
Alle feltene skal fylles med tall. Noen tall er fylt inn på forhånd, og dette utgjør summen av tallene i de to feltene under. Du må sette inn begge tallene i de to tilstøtende feltene for å finne tallet i feltet over, og motsatt, du finner tallet i et felt ved å trekke tallet i feltet ved siden av fra tallet i feltet over.
Lett
Bokstavene i ordet under har blandet seg litt. Kan du nne fram til riktig ord ved å plassere bokstavene i riktig rekkefølge i de hvite feltene?
Den grå teksten på siden gir deg noen hint. Skjul teksten om du ikke vil ha hjelp.
Middels
Ordet starter med bokstaven P
En fugleart
Den nest minste uglen i Norge
PERLEUGLE
Vanskelig
Finn alle ordene. Ordene kan stå vannrett, loddrett eller diagonalt, og kan ofte stå skrevet baklengs.
ABORTDEBATT ANATOM BLINDESKRIFT EMANSIPERING JUBELÅR KEISERKRONING LØGNER NARKOTIKALIGA
NEVROLOG PRAKSISÅR ROMHELG SKJEBNEÅR TOSSET UBESLEKTET UPÅKLEDD

PARATS TRENINGSSIDE MED HJERNETRIM
Sender du oss løsningen på alle oppgavene på denne siden, er du med i trekningen av en Elvang Latitude alpakka-pledd av 50 prosent alpakkaull, 40 prosent fåreull og 10 prosent mikrofiber. Pleddet er Fair Tradesertifisert. Målene er 130x200 centimeter (se foto).

Frist for å sende inn løsningen er 3. september 2018. Vi trekker én vinner hver gang. Send løsningen til redaksjonen, enten på e-post til trygve. bergsland@parat.com, eller ordinær post til: Parat, postboks 9029 Grønland, 0133 Oslo. Husk å merke e-posten/konvolutten «Hjernetrim 2/2018». Vinneren av hjernetrim i 1/2018 er Kåre Steinsvik, fra Straume.
En kveld satt jeg og snakket med min sønn på sju år og min datter på elleve, om forskjellige ting.
Det var da jeg stilte dem spørsmålet; vet dere hva en fagforening gjør, hva er Parat?
Det var kanskje litt urettferdig å stille en sju og en elleveåring et slikt spørsmål, og jeg forventet ikke egentlig at de skulle gi meg et utfyllende svar. Det var mest for å få til en prat om temaet. Han på sju svarte at fagforeninger gjør slik at de som jobber får lønnen og ferien sin, mens hun på elleve svarte at Parat også er et blad.
Mine barn er nok noe påvirket av farens jobb. Likevel tror jeg svarene også kan gjenspeile opplevelsen mange av medlemmene i Parat sitter igjen med. For mange av våre medlemmer er Parat i hovedsak bladet som kommer i postboksen. Svært mange av våre medlemmer har problemfrie og trygge jobber, og har sjelden eller aldri behov for å kontakte fagforeningen og få bistand. Parat er tryggheten de har i bakhånd, eller også den som ordner billige forsikringer.
For deg som har lokal tillitsvalgt, er det kanskje det du ville svart på mitt spørsmål; den tillitsvalgte er Parat for meg. Det er nettopp derfor vi satser store deler av organisasjonens ressurser på å ha så mange gode og godt skolerte tillitsvalgte som Parat har. Våre tillitsvalgte er organisasjonens ambassadører. De skal ha de beste forutsetningene for å både rekruttere nye medlemmer, ivareta dem vi har, og representere Parat og medlemmene overfor arbeidsgiver på en god måte når det er nødvendig.
Kanskje er du imidlertid et av de mange fornøyde medlemmene som har fått bistand fra noen av våre om lag 60 kompetente ansatte i vår administrasjon. For dem som har opplevd profesjonaliteten i vårt administrative apparat som ikke bare er en støtte for de tillitsvalgte, men også tilgjengelig for hvert enkelt medlem, blir ofte verdien av Parat veldig synlig.
Våre ansatte løser store og små saker for medlemmer og grupper hver dag hele året. Mange av våre medlemmer har ikke en tillitsvalgt å be om hjelp. For den enkelte er tryggheten i å ha noen å kontakte når sjefen endrer bonusavtalen med tilbakevirkende kraft, når overtidsbetalingen uteblir, eller når du ikke får fast jobb etter fem års vikariat i samme stilling, viktig. For den enkelte er det ingenting som er viktigere enn trygghet i jobben, og hjelp når du trenger det.
Parats mål er å gi trygghet til hver enkelt og bidra til rettferdighet i arbeidslivet, samtidig som vi er med på å skape gode arbeids
plasser. Det norske arbeidslivet er veldig bra. Likevel finnes det helt sikkert noe som kan bli bedre, og jeg tror på at ny teknologi og samarbeid mellom arbeidstaker og arbeidsgiver både vil skape jobber og sikre overgangen til nye jobber for mange av oss.
I Parat har vi vokst til nesten 40 000 medlemmer. Veksten kommer av at vi leverer kvalitet, og at medlemmene vi har er fornøyde og sier det til kolleger og venner.
Nylig kom Personellforbundet med sine om lag 3000 medlemmer inn i Parat og blir en underorganisasjon med navnet «Parat forsvar». De er sivilt ansatte og vervede personell i Forsvaret. Jeg vil gjerne ønske dem alle velkommen, og håper Parat vil bli akkurat det de trenger både som gruppe og enkeltmedlemmer.
For alle våre 40 000 medlemmer må vi levere og være parat. Vi må levere i bladet, vi må levere gjennom den tillitsvalgtes muligheter og ved våre ansattes tilgjengelighet og kompetanse. Akkurat nå i tiden fremover håper jeg imidlertid vi som fagforening kan være noe du tenker på som en bidragsyter til at du forhåpentlig får ta din velfortjente ferie.
God sommer!

Vegard Einan
Nestleder i Parat
Twitter: @vegardeinan
Facebook: facebook.com/ VegardNestlederParat/








Du har sikkert hørt om «dårlige svømmere» og at kvinner venter for lenge med å få barn. Men er det de eneste årsakene til infertilitet?
Lær mer om årsakene, behandlingsalternativer, som f.eks. IVF, og nyttige råd om legemiddelhåndtering.



Visste du at hormonell prevensjon ikke bare brukes for å unngå graviditet?
Hva er fordelene og ulempene med de ulike prevensjonsmidlene?
Lær mer om gode råd for trygg og sikker bruk av hormonell prevensjon.



Hva kan kvalme skyldes?
Hvorfor brukes det så mange ulike legemidler i behandlingen?
Lær mer om årsaker til kvalme, hvilken type kvalme de ulike legemidlene brukes ved og generelle behandlingsprinsipper.


